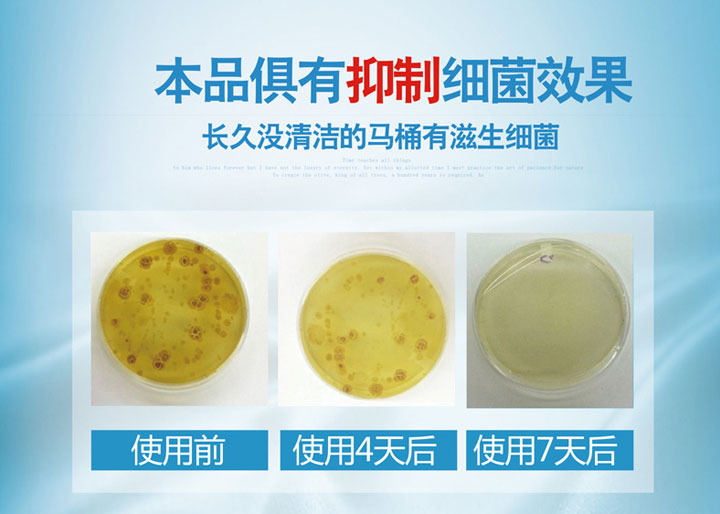
alt

Дезодорант, прочный гигиенический туалет, ароматное чистящее средство для домашнего использования

Цена: 391руб. (¥18.5)
Артикул: 577929179242
Цена указана со скидкой: 50%
Старая цена: 782р.
Вес товара: ~0.7 кг. Указан усредненный вес, который может отличаться от фактического. Не включен в цену, оплачивается при получении.
Описание товараPHA+PHAgc3R5bGU9Im92ZXJmbG93OiBoaWRkZW47cGFkZGluZzogMC4wcHg7bWFyZ2luOiAwLjBweCAwLjBweCAwLjBweCAwLjBweDsiPjxpbWcgd2lkdGg9IjEiIGhlaWdodD0iMSIgYm9yZGVyPSIwIiB1c2VtYXA9IiNvd2lrZV8xdW5sNnFibWFxZ3RxMyIgYWx0PSIiIHNyYz0iaHR0cHM6Ly9pbWcuYWxpY2RuLmNvbS9pbWdleHRyYS9pMi83NDg3Mzk1MTIvVEIyUE04SGdGWFhYWGJGWHBYWFhYWFhYWFhYLTc0ODczOTUxMi5naWY/b3dpa2VfMWk9bmw2cWJtYXFndHEzIj48L3A+PHRhYmxlIGNlbGxwYWRkaW5nPSIwIiBjZWxsc3BhY2luZz0iMCIgc3R5bGU9Im1hcmdpbjogYXV0bztib3JkZXI6IDAuMHB4O3RleHQtYWxpZ246IGNlbnRlcjtib3JkZXI6IDA7IiBiYWNrZ3JvdW5kPSJodHRwczovL2ltZy5hbGljZG4uY29tL2ltZ2V4dHJhL2kyLzc0ODczOTUxMi9UQjJQTThIZ0ZYWFhYYkZYcFhYWFhYWFhYWFgtNzQ4NzM5NTEyLmdpZj9vd2lrZV8yYj1ubDZxYm1hcWd0cTMiPjx0cj48dGQgYWxpZ249ImNlbnRlciIgc3R5bGU9ImJvcmRlcjogMC4wcHg7Ij48aW1nIGFsdD0iIiBzcmM9Imh0dHBzOi8vaW1nLmFsaWNkbi5jb20vaW1nZXh0cmEvaTQvMTM5NjYzOTQ5L08xQ04wMTFmMmdXZUJ6b3g4bVhPY18hITEzOTY2Mzk0OS5qcGciPjwvdGQ+PC90cj48dHI+PHRkIGhlaWdodD0iMCIgc3R5bGU9ImJvcmRlcjogMC4wcHg7Ij48ZGl2IHN0eWxlPSJvdmVyZmxvdzogaGlkZGVuOyI+PGEgbmFtZT0idHBsX25sNnFibWFxZ3RxM19vY2VudGVyIj48aW1nIHdpZHRoPSIxIiBoZWlnaHQ9IjEiIGJvcmRlcj0iMCIgdXNlbWFwPSIjb3dpa2VfY2VudGVybmw2cWJtYXFndHEzIiBhbHQ9IiIgc3JjPSJodHRwczovL2ltZy5hbGljZG4uY29tL2ltZ2V4dHJhL2kyLzc0ODczOTUxMi9UQjJQTThIZ0ZYWFhYYkZYcFhYWFhYWFhYWFgtNzQ4NzM5NTEyLmdpZj9vd2lrZV9jZW50ZXI9bmw2cWJtYXFndHEzIj48L2E+PC9kaXY+PC90ZD48L3RyPjwvdGFibGU+PHAgc3R5bGU9Im92ZXJmbG93OiBoaWRkZW47cGFkZGluZzogMC4wcHg7bWFyZ2luOiAwLjBweCAwLjBweCAwLjBweCAwLjBweDsiPjxpbWcgd2lkdGg9IjEiIGhlaWdodD0iMSIgYm9yZGVyPSIwIiB1c2VtYXA9IiNvd2lrZV8wdW5sNnFibWFxZ3RxMyIgYWx0PSIiIHNyYz0iaHR0cHM6Ly9pbWcuYWxpY2RuLmNvbS9pbWdleHRyYS9pMi83NDg3Mzk1MTIvVEIyUE04SGdGWFhYWGJGWHBYWFhYWFhYWFhYLTc0ODczOTUxMi5naWY/b3dpa2VfMGk9bmw2cWJtYXFndHEzIj48L3A+PHAgc3R5bGU9Im92ZXJmbG93OiBoaWRkZW47cGFkZGluZzogMC4wcHg7bWFyZ2luOiAxMC4wcHggMC4wcHggMC4wcHggMC4wcHg7Ij48aW1nIHdpZHRoPSIxIiBoZWlnaHQ9IjEiIGJvcmRlcj0iMCIgdXNlbWFwPSIjb3dpa2VfMXU5N2Y3MmExNGVmYmU1NCIgc3JjPSJodHRwczovL2ltZy5hbGljZG4uY29tL2ltZ2V4dHJhL2kyLzc0ODczOTUxMi9UQjJQTThIZ0ZYWFhYYkZYcFhYWFhYWFhYWFgtNzQ4NzM5NTEyLmdpZj9vd2lrZV8xaT05N2Y3MmExNGVmYmU1NCI+PC9wPjx0YWJsZSBjZWxscGFkZGluZz0iMCIgY2VsbHNwYWNpbmc9IjAiIHN0eWxlPSJtYXJnaW46IGF1dG87Ym9yZGVyOiAwLjBweDt0ZXh0LWFsaWduOiBjZW50ZXI7Ym9yZGVyOiAwOyIgYmFja2dyb3VuZD0iaHR0cHM6Ly9pbWcuYWxpY2RuLmNvbS9pbWdleHRyYS9pMi83NDg3Mzk1MTIvVEIyUE04SGdGWFhYWGJGWHBYWFhYWFhYWFhYLTc0ODczOTUxMi5naWY/b3dpa2VfMmI9OTdmNzJhMTRlZmJlNTQiPjx0cj48dGQgYWxpZ249ImNlbnRlciIgc3R5bGU9ImJvcmRlcjogMC4wcHg7Ij48dGFibGUgY2VsbHNwYWNpbmc9IjAiIGNlbGxwYWRkaW5nPSIwIiBiYWNrZ3JvdW5kPSJodHRwczovL2ltZy5hbGljZG4uY29tL2ltZ2V4dHJhL2kzLzEzOTY2Mzk0OS9UQjJhVW9LZmN0bnB1RmpTWkZLWFhhbEZGWGFfISExMzk2NjM5NDkuanBnIiBzdHlsZT0iaGVpZ2h0OiAxMTcuMHB4O3dpZHRoOiA3NTAuMHB4O2JvcmRlcjogMC4wcHg7YmFja2dyb3VuZC1yZXBlYXQ6IG5vLXJlcGVhdDtmb250LXNpemU6IDEyLjBweDsiPjx0cj48dGQgd2lkdGg9Ijg5IiBoZWlnaHQ9IjExNyI+PC90ZD48dGQgd2lkdGg9IjIiIGhlaWdodD0iMTE3Ij48L3RkPjx0ZCB3aWR0aD0iMTU1IiBoZWlnaHQ9IjExNyI+PC90ZD48dGQgd2lkdGg9IjUiIGhlaWdodD0iMTE3Ij48L3RkPjx0ZCB3aWR0aD0iMTYxIiBoZWlnaHQ9IjExNyI+PC90ZD48dGQgd2lkdGg9IjMiIGhlaWdodD0iMTE3Ij48L3RkPjx0ZCB3aWR0aD0iMTY3IiBoZWlnaHQ9IjExNyI+PC90ZD48dGQgd2lkdGg9IjEiIGhlaWdodD0iMTE3Ij48L3RkPjx0ZCB3aWR0aD0iMTY3IiBoZWlnaHQ9IjExNyI+PC90ZD48L3RyPjwvdGFibGU+PC90ZD48L3RyPjx0cj48dGQgaGVpZ2h0PSIwIiBzdHlsZT0iYm9yZGVyOiAwLjBweDsiPjxkaXYgc3R5bGU9Im92ZXJmbG93OiBoaWRkZW47Ij48YSBuYW1lPSJ0cGxfOTdmNzJhMTRlZmJlNTRfb2NlbnRlciI+PGltZyB3aWR0aD0iMSIgaGVpZ2h0PSIxIiBib3JkZXI9IjAiIHVzZW1hcD0iI293aWtlX2NlbnRlcjk3ZjcyYTE0ZWZiZTU0IiBzcmM9Imh0dHBzOi8vaW1nLmFsaWNkbi5jb20vaW1nZXh0cmEvaTIvNzQ4NzM5NTEyL1RCMlBNOEhnRlhYWFhiRlhwWFhYWFhYWFhYWC03NDg3Mzk1MTIuZ2lmP293aWtlX2NlbnRlcj05N2Y3MmExNGVmYmU1NCI+PC9hPjwvZGl2PjwvdGQ+PC90cj48L3RhYmxlPjxwIHN0eWxlPSJvdmVyZmxvdzogaGlkZGVuO3BhZGRpbmc6IDAuMHB4O21hcmdpbjogMC4wcHggMC4wcHggMTAuMHB4IDAuMHB4OyI+PGltZyB3aWR0aD0iMSIgaGVpZ2h0PSIxIiBib3JkZXI9IjAiIHVzZW1hcD0iI293aWtlXzB1OTdmNzJhMTRlZmJlNTQiIHNyYz0iaHR0cHM6Ly9pbWcuYWxpY2RuLmNvbS9pbWdleHRyYS9pMi83NDg3Mzk1MTIvVEIyUE04SGdGWFhYWGJGWHBYWFhYWFhYWFhYLTc0ODczOTUxMi5naWY/b3dpa2VfMGk9OTdmNzJhMTRlZmJlNTQiPjwvcD48cCBzdHlsZT0ib3ZlcmZsb3c6IGhpZGRlbjtwYWRkaW5nOiAwLjBweDttYXJnaW46IDEwLjBweCAwLjBweCAwLjBweCAwLjBweDsiPjxpbWcgd2lkdGg9IjEiIGhlaWdodD0iMSIgYm9yZGVyPSIwIiB1c2VtYXA9IiNvd2lrZV8xdTMxNzAyMTcxMDQ3MzAzMzQ4ODkiIHNyYz0iaHR0cHM6Ly9pbWcuYWxpY2RuLmNvbS9pbWdleHRyYS9pMi83NDg3Mzk1MTIvVEIyUE04SGdGWFhYWGJGWHBYWFhYWFhYWFhYLTc0ODczOTUxMi5naWY/b3dpa2VfMWk9MzE3MDIxNzEwNDczMDMzNDg4OSI+PC9wPjx0YWJsZSBjZWxscGFkZGluZz0iMCIgY2VsbHNwYWNpbmc9IjAiIHN0eWxlPSJtYXJnaW46IGF1dG87Ym9yZGVyOiAwLjBweDt0ZXh0LWFsaWduOiBjZW50ZXI7Ym9yZGVyOiAwOyIgYmFja2dyb3VuZD0iaHR0cHM6Ly9pbWcuYWxpY2RuLmNvbS9pbWdleHRyYS9pMi83NDg3Mzk1MTIvVEIyUE04SGdGWFhYWGJGWHBYWFhYWFhYWFhYLTc0ODczOTUxMi5naWY/b3dpa2VfMmI9MzE3MDIxNzEwNDczMDMzNDg4OSI+PHRyPjx0ZCBhbGlnbj0iY2VudGVyIiBzdHlsZT0iYm9yZGVyOiAwLjBweDsiPjxkaXYgc3R5bGU9IndpZHRoOiA3NTAuMHB4O21hcmdpbjogYXV0bzsiPjx0YWJsZSB3aWR0aD0iNzUwIiBoZWlnaHQ9IjMxNiIgYm9yZGVyPSIwIiBjZWxsc3BhY2luZz0iMCIgY2VsbHBhZGRpbmc9IjAiIHN0eWxlPSJtYXJnaW46IGF1dG87Zm9udC1mYW1pbHk6IOW+rui9r+mbhem7kTsiPjx0cj48dGQgd2lkdGg9IjMzJSIgYWxpZ249ImxlZnQiPjxkaXYgc3R5bGU9IndpZHRoOiAyMzAuMHB4O2ZvbnQtZmFtaWx5OiDlvq7ova/pm4Xpu5E7YmFja2dyb3VuZDogI2U4MzY0Mjtib3JkZXItcmlnaHQ6IDEuMHB4ICNlMWUwZGUgc29saWQ7Ym9yZGVyLXRvcDogMS4wcHggI2UxZTBkZSBzb2xpZDtib3JkZXItYm90dG9tOiAxLjBweCAjZTFlMGRlIHNvbGlkO2JvcmRlci1sZWZ0OiAxLjBweCAjZTFlMGRlIHNvbGlkO3BhZGRpbmc6IDcuMHB4O21hcmdpbjogYXV0bzsiPjxhIGhyZWY9Imh0dHA6Ly9pdGVtLnRhb2Jhby5jb20vaXRlbS5odG0/aWQ9NjMwNzA4NTg3NjUwIiB0YXJnZXQ9Il9ibGFuayIgc3R5bGU9ImhlaWdodDogMjMwLjBweDtkaXNwbGF5OiBibG9jazttYXJnaW4tYm90dG9tOiA1LjBweDtvdmVyZmxvdzogaGlkZGVuOyI+PGltZyBzcmM9Imh0dHBzOi8vaW1nLmFsaWNkbi5jb20vYmFvL3VwbG9hZGVkL2kzLzEzOTY2Mzk0OS9PMUNOMDFsUmNwa0UxZjJnaDhKS0NHaF8hITAtaXRlbV9waWMuanBnXzMxMHgzMTAuanBnIiB3aWR0aD0iMjMwIiBoZWlnaHQ9IjIzMCIgYm9yZGVyPSIwIj48L2E+PGRpdj48dGFibGUgc3R5bGU9Im1hcmdpbi1ib3R0b206IDUuMHB4OyIgYWxpZ249ImNlbnRlciIgYm9yZGVyY29sb3I9IiNGRkZGRkYiIGJvcmRlcj0iMCIgY2VsbHBhZGRpbmc9IjAiIGNlbGxzcGFjaW5nPSIwIiB3aWR0aD0iMjMwIiBoZWlnaHQ9IjMyIj48dHI+PHRkIGJnY29sb3I9IiNlODM2NDIiIHdpZHRoPSI2MCUiIGFsaWduPSJsZWZ0Ij48ZGl2IHN0eWxlPSJwYWRkaW5nOiAwLjBweCA1LjBweDtvdmVyZmxvdzogaGlkZGVuO3RleHQtYWxpZ246IGxlZnQ7Zm9udC1zaXplOiAxMi4wcHg7dGV4dC1kZWNvcmF0aW9uOiBsaW5lLXRocm91Z2g7Y29sb3I6ICNmZmZmZmY7Ij7QptC10L3QsDogNSw4PC9kaXY+PGRpdiBzdHlsZT0icGFkZGluZy1sZWZ0OiA1LjBweDtvdmVyZmxvdzogaGlkZGVuO3RleHQtYWxpZ246IGxlZnQ7Zm9udC1zaXplOiAxMi4wcHg7Y29sb3I6ICNmZmZmZmY7Ij7QotC10LrRg9GJ0LDRjyDRhtC10L3QsDog77+lIO+/pTxmb250IHN0eWxlPSJmb250LXNpemU6IDIyLjBweDtsaW5lLWhlaWdodDogMjIuMHB4OyI+IDIuOTwvZm9udD48L2Rpdj48L3RkPjx0ZCBzdHlsZT0icGFkZGluZy1sZWZ0OiAxMi4wcHg7IiB3aWR0aD0iNDAlIiBhbGlnbj0iY2VudGVyIiB2YWxpZ249Im1pZGRsZSI+PGRpdiBzdHlsZT0icGFkZGluZzogMi4wcHg7bGluZS1oZWlnaHQ6IDI2LjBweDtiYWNrZ3JvdW5kLWNvbG9yOiAjZTgzNjQyO3RleHQtYWxpZ246IGNlbnRlcjtvdmVyZmxvdzogaGlkZGVuO2ZvbnQtc2l6ZTogMTQuMHB4O2NvbG9yOiAjZmZmZmZmOyI+0JDRgNGC0LXRhNCw0LrRgiDQs9GA0LXRhtC60L7Qs9C+INC+0YDQtdGF0LA8L2Rpdj48ZGl2IHN0eWxlPSJib3JkZXItcmlnaHQ6IDIuMHB4ICNjNmM2YzYgc29saWQ7Ym9yZGVyLWJvdHRvbTogMi4wcHggI2M2YzZjNiBzb2xpZDtib3JkZXItbGVmdDogMi4wcHggI2M2YzZjNiBzb2xpZDttYXJnaW46IDAgNC4wcHg7Ym9yZGVyLXRvcDogbm9uZTt0ZXh0LWFsaWduOiBjZW50ZXI7b3ZlcmZsb3c6IGhpZGRlbjtmb250LXNpemU6IDE0LjBweDtjb2xvcjogIzAwMDAwMDsiPtGC0LXQvNCwPC9kaXY+PC90ZD48L3RyPjwvdGFibGU+PC9kaXY+PC9kaXY+PC90ZD48dGQgd2lkdGg9IjM0JSIgYWxpZ249ImxlZnQiPjxkaXYgc3R5bGU9IndpZHRoOiAyMzAuMHB4O2ZvbnQtZmFtaWx5OiDlvq7ova/pm4Xpu5E7YmFja2dyb3VuZDogI2U4MzY0Mjtib3JkZXItcmlnaHQ6IDEuMHB4ICNlMWUwZGUgc29saWQ7Ym9yZGVyLXRvcDogMS4wcHggI2UxZTBkZSBzb2xpZDtib3JkZXItYm90dG9tOiAxLjBweCAjZTFlMGRlIHNvbGlkO2JvcmRlci1sZWZ0OiAxLjBweCAjZTFlMGRlIHNvbGlkO3BhZGRpbmc6IDcuMHB4O21hcmdpbjogYXV0bzsiPjxhIGhyZWY9Imh0dHA6Ly9pdGVtLnRhb2Jhby5jb20vaXRlbS5odG0/aWQ9NjMwNzEwOTc5ODYxIiB0YXJnZXQ9Il9ibGFuayIgc3R5bGU9ImhlaWdodDogMjMwLjBweDtkaXNwbGF5OiBibG9jazttYXJnaW4tYm90dG9tOiA1LjBweDtvdmVyZmxvdzogaGlkZGVuOyI+PGltZyBzcmM9Imh0dHBzOi8vaW1nLmFsaWNkbi5jb20vYmFvL3VwbG9hZGVkL2kxLzEzOTY2Mzk0OS9PMUNOMDFFbW03NU4xZjJnaEVGZDdjZl8hITAtaXRlbV9waWMuanBnXzMxMHgzMTAuanBnIiB3aWR0aD0iMjMwIiBoZWlnaHQ9IjIzMCIgYm9yZGVyPSIwIj48L2E+PGRpdj48dGFibGUgc3R5bGU9Im1hcmdpbi1ib3R0b206IDUuMHB4OyIgYWxpZ249ImNlbnRlciIgYm9yZGVyY29sb3I9IiNGRkZGRkYiIGJvcmRlcj0iMCIgY2VsbHBhZGRpbmc9IjAiIGNlbGxzcGFjaW5nPSIwIiB3aWR0aD0iMjMwIiBoZWlnaHQ9IjMyIj48dHI+PHRkIGJnY29sb3I9IiNlODM2NDIiIHdpZHRoPSI2MCUiIGFsaWduPSJsZWZ0Ij48ZGl2IHN0eWxlPSJwYWRkaW5nOiAwLjBweCA1LjBweDtvdmVyZmxvdzogaGlkZGVuO3RleHQtYWxpZ246IGxlZnQ7Zm9udC1zaXplOiAxMi4wcHg7dGV4dC1kZWNvcmF0aW9uOiBsaW5lLXRocm91Z2g7Y29sb3I6ICNmZmZmZmY7Ij7QptC10L3QsDogMTcsNjwvZGl2PjxkaXYgc3R5bGU9InBhZGRpbmctbGVmdDogNS4wcHg7b3ZlcmZsb3c6IGhpZGRlbjt0ZXh0LWFsaWduOiBsZWZ0O2ZvbnQtc2l6ZTogMTIuMHB4O2NvbG9yOiAjZmZmZmZmOyI+0KLQtdC60YPRidCw0Y8g0YbQtdC90LA6IO+/pSDvv6U8Zm9udCBzdHlsZT0iZm9udC1zaXplOiAyMi4wcHg7bGluZS1oZWlnaHQ6IDIyLjBweDsiPiA4Ljg8L2ZvbnQ+PC9kaXY+PC90ZD48dGQgc3R5bGU9InBhZGRpbmctbGVmdDogMTIuMHB4OyIgd2lkdGg9IjQwJSIgYWxpZ249ImNlbnRlciIgdmFsaWduPSJtaWRkbGUiPjxkaXYgc3R5bGU9InBhZGRpbmc6IDIuMHB4O2xpbmUtaGVpZ2h0OiAyNi4wcHg7YmFja2dyb3VuZC1jb2xvcjogI2U4MzY0Mjt0ZXh0LWFsaWduOiBjZW50ZXI7b3ZlcmZsb3c6IGhpZGRlbjtmb250LXNpemU6IDE0LjBweDtjb2xvcjogI2ZmZmZmZjsiPtCi0LXQv9C70YvQuSDQtNCy0L7RgNC10YY8L2Rpdj48ZGl2IHN0eWxlPSJib3JkZXItcmlnaHQ6IDIuMHB4ICNjNmM2YzYgc29saWQ7Ym9yZGVyLWJvdHRvbTogMi4wcHggI2M2YzZjNiBzb2xpZDtib3JkZXItbGVmdDogMi4wcHggI2M2YzZjNiBzb2xpZDttYXJnaW46IDAgNC4wcHg7Ym9yZGVyLXRvcDogbm9uZTt0ZXh0LWFsaWduOiBjZW50ZXI7b3ZlcmZsb3c6IGhpZGRlbjtmb250LXNpemU6IDE0LjBweDtjb2xvcjogIzAwMDAwMDsiPtGC0LXQvNCwPC9kaXY+PC90ZD48L3RyPjwvdGFibGU+PC9kaXY+PC9kaXY+PC90ZD48dGQgd2lkdGg9IjMzJSIgYWxpZ249ImxlZnQiPjxkaXYgc3R5bGU9IndpZHRoOiAyMzAuMHB4O2ZvbnQtZmFtaWx5OiDlvq7ova/pm4Xpu5E7YmFja2dyb3VuZDogI2U4MzY0Mjtib3JkZXItcmlnaHQ6IDEuMHB4ICNlMWUwZGUgc29saWQ7Ym9yZGVyLXRvcDogMS4wcHggI2UxZTBkZSBzb2xpZDtib3JkZXItYm90dG9tOiAxLjBweCAjZTFlMGRlIHNvbGlkO2JvcmRlci1sZWZ0OiAxLjBweCAjZTFlMGRlIHNvbGlkO3BhZGRpbmc6IDcuMHB4O21hcmdpbjogYXV0bzsiPjxhIGhyZWY9Imh0dHA6Ly9pdGVtLnRhb2Jhby5jb20vaXRlbS5odG0/aWQ9NjMwNDIyMDM0MDIwIiB0YXJnZXQ9Il9ibGFuayIgc3R5bGU9ImhlaWdodDogMjMwLjBweDtkaXNwbGF5OiBibG9jazttYXJnaW4tYm90dG9tOiA1LjBweDtvdmVyZmxvdzogaGlkZGVuOyI+PGltZyBzcmM9Imh0dHBzOi8vaW1nLmFsaWNkbi5jb20vYmFvL3VwbG9hZGVkL2k0LzEzOTY2Mzk0OS9PMUNOMDE3dlpYdWExZjJnaEpMejZpNl8hITAtaXRlbV9waWMuanBnXzMxMHgzMTAuanBnIiB3aWR0aD0iMjMwIiBoZWlnaHQ9IjIzMCIgYm9yZGVyPSIwIj48L2E+PGRpdj48dGFibGUgc3R5bGU9Im1hcmdpbi1ib3R0b206IDUuMHB4OyIgYWxpZ249ImNlbnRlciIgYm9yZGVyY29sb3I9IiNGRkZGRkYiIGJvcmRlcj0iMCIgY2VsbHBhZGRpbmc9IjAiIGNlbGxzcGFjaW5nPSIwIiB3aWR0aD0iMjMwIiBoZWlnaHQ9IjMyIj48dHI+PHRkIGJnY29sb3I9IiNlODM2NDIiIHdpZHRoPSI2MCUiIGFsaWduPSJsZWZ0Ij48ZGl2IHN0eWxlPSJwYWRkaW5nOiAwLjBweCA1LjBweDtvdmVyZmxvdzogaGlkZGVuO3RleHQtYWxpZ246IGxlZnQ7Zm9udC1zaXplOiAxMi4wcHg7dGV4dC1kZWNvcmF0aW9uOiBsaW5lLXRocm91Z2g7Y29sb3I6ICNmZmZmZmY7Ij7QptC10L3QsDogNyw2PC9kaXY+PGRpdiBzdHlsZT0icGFkZGluZy1sZWZ0OiA1LjBweDtvdmVyZmxvdzogaGlkZGVuO3RleHQtYWxpZ246IGxlZnQ7Zm9udC1zaXplOiAxMi4wcHg7Y29sb3I6ICNmZmZmZmY7Ij7QotC10LrRg9GJ0LDRjyDRhtC10L3QsDog77+lIO+/pTxmb250IHN0eWxlPSJmb250LXNpemU6IDIyLjBweDtsaW5lLWhlaWdodDogMjIuMHB4OyI+IDMuODwvZm9udD48L2Rpdj48L3RkPjx0ZCBzdHlsZT0icGFkZGluZy1sZWZ0OiAxMi4wcHg7IiB3aWR0aD0iNDAlIiBhbGlnbj0iY2VudGVyIiB2YWxpZ249Im1pZGRsZSI+PGRpdiBzdHlsZT0icGFkZGluZzogMi4wcHg7bGluZS1oZWlnaHQ6IDI2LjBweDtiYWNrZ3JvdW5kLWNvbG9yOiAjZTgzNjQyO3RleHQtYWxpZ246IGNlbnRlcjtvdmVyZmxvdzogaGlkZGVuO2ZvbnQtc2l6ZTogMTQuMHB4O2NvbG9yOiAjZmZmZmZmOyI+0JHQsNGA0LDQsdCw0L3QvdGL0LUg0LvQuNC/0LrQuNC1INCy0L7Qu9C+0YHRizwvZGl2PjxkaXYgc3R5bGU9ImJvcmRlci1yaWdodDogMi4wcHggI2M2YzZjNiBzb2xpZDtib3JkZXItYm90dG9tOiAyLjBweCAjYzZjNmM2IHNvbGlkO2JvcmRlci1sZWZ0OiAyLjBweCAjYzZjNmM2IHNvbGlkO21hcmdpbjogMCA0LjBweDtib3JkZXItdG9wOiBub25lO3RleHQtYWxpZ246IGNlbnRlcjtvdmVyZmxvdzogaGlkZGVuO2ZvbnQtc2l6ZTogMTQuMHB4O2NvbG9yOiAjMDAwMDAwOyI+0YLQtdC80LA8L2Rpdj48L3RkPjwvdHI+PC90YWJsZT48L2Rpdj48L2Rpdj48L3RkPjwvdHI+PC90YWJsZT48dGFibGUgd2lkdGg9Ijc1MCIgaGVpZ2h0PSIzMTYiIGJvcmRlcj0iMCIgY2VsbHNwYWNpbmc9IjAiIGNlbGxwYWRkaW5nPSIwIiBzdHlsZT0ibWFyZ2luOiBhdXRvO2ZvbnQtZmFtaWx5OiDlvq7ova/pm4Xpu5E7Ij48dHI+PHRkIHdpZHRoPSIzMyUiIGFsaWduPSJsZWZ0Ij48ZGl2IHN0eWxlPSJ3aWR0aDogMjMwLjBweDtmb250LWZhbWlseTog5b6u6L2v6ZuF6buRO2JhY2tncm91bmQ6ICNlODM2NDI7Ym9yZGVyLXJpZ2h0OiAxLjBweCAjZTFlMGRlIHNvbGlkO2JvcmRlci10b3A6IDEuMHB4ICNlMWUwZGUgc29saWQ7Ym9yZGVyLWJvdHRvbTogMS4wcHggI2UxZTBkZSBzb2xpZDtib3JkZXItbGVmdDogMS4wcHggI2UxZTBkZSBzb2xpZDtwYWRkaW5nOiA3LjBweDttYXJnaW46IGF1dG87Ij48YSBocmVmPSJodHRwOi8vaXRlbS50YW9iYW8uY29tL2l0ZW0uaHRtP2lkPTYzMTg1Nzc5MTQxMSIgdGFyZ2V0PSJfYmxhbmsiIHN0eWxlPSJoZWlnaHQ6IDIzMC4wcHg7ZGlzcGxheTogYmxvY2s7bWFyZ2luLWJvdHRvbTogNS4wcHg7b3ZlcmZsb3c6IGhpZGRlbjsiPjxpbWcgc3JjPSJodHRwczovL2ltZy5hbGljZG4uY29tL2Jhby91cGxvYWRlZC9pMy8xMzk2NjM5NDkvTzFDTjAxOGhtbjNTMWYyZ2hWQmt5MXpfISEwLWl0ZW1fcGljLmpwZ18zMTB4MzEwLmpwZyIgd2lkdGg9IjIzMCIgaGVpZ2h0PSIyMzAiIGJvcmRlcj0iMCI+PC9hPjxkaXY+PHRhYmxlIHN0eWxlPSJtYXJnaW4tYm90dG9tOiA1LjBweDsiIGFsaWduPSJjZW50ZXIiIGJvcmRlcmNvbG9yPSIjRkZGRkZGIiBib3JkZXI9IjAiIGNlbGxwYWRkaW5nPSIwIiBjZWxsc3BhY2luZz0iMCIgd2lkdGg9IjIzMCIgaGVpZ2h0PSIzMiI+PHRyPjx0ZCBiZ2NvbG9yPSIjZTgzNjQyIiB3aWR0aD0iNjAlIiBhbGlnbj0ibGVmdCI+PGRpdiBzdHlsZT0icGFkZGluZzogMC4wcHggNS4wcHg7b3ZlcmZsb3c6IGhpZGRlbjt0ZXh0LWFsaWduOiBsZWZ0O2ZvbnQtc2l6ZTogMTIuMHB4O3RleHQtZGVjb3JhdGlvbjogbGluZS10aHJvdWdoO2NvbG9yOiAjZmZmZmZmOyI+0KbQtdC90LA6IDksODwvZGl2PjxkaXYgc3R5bGU9InBhZGRpbmctbGVmdDogNS4wcHg7b3ZlcmZsb3c6IGhpZGRlbjt0ZXh0LWFsaWduOiBsZWZ0O2ZvbnQtc2l6ZTogMTIuMHB4O2NvbG9yOiAjZmZmZmZmOyI+0KLQtdC60YPRidCw0Y8g0YbQtdC90LA6IO+/pSDvv6U8Zm9udCBzdHlsZT0iZm9udC1zaXplOiAyMi4wcHg7bGluZS1oZWlnaHQ6IDIyLjBweDsiPiA0Ljk8L2ZvbnQ+PC9kaXY+PC90ZD48dGQgc3R5bGU9InBhZGRpbmctbGVmdDogMTIuMHB4OyIgd2lkdGg9IjQwJSIgYWxpZ249ImNlbnRlciIgdmFsaWduPSJtaWRkbGUiPjxkaXYgc3R5bGU9InBhZGRpbmc6IDIuMHB4O2xpbmUtaGVpZ2h0OiAyNi4wcHg7YmFja2dyb3VuZC1jb2xvcjogI2U4MzY0Mjt0ZXh0LWFsaWduOiBjZW50ZXI7b3ZlcmZsb3c6IGhpZGRlbjtmb250LXNpemU6IDE0LjBweDtjb2xvcjogI2ZmZmZmZjsiPtCk0YDQuNC60LDQtNC10LvRjNC60LAg0LvQvtC20LrQuDwvZGl2PjxkaXYgc3R5bGU9ImJvcmRlci1yaWdodDogMi4wcHggI2M2YzZjNiBzb2xpZDtib3JkZXItYm90dG9tOiAyLjBweCAjYzZjNmM2IHNvbGlkO2JvcmRlci1sZWZ0OiAyLjBweCAjYzZjNmM2IHNvbGlkO21hcmdpbjogMCA0LjBweDtib3JkZXItdG9wOiBub25lO3RleHQtYWxpZ246IGNlbnRlcjtvdmVyZmxvdzogaGlkZGVuO2ZvbnQtc2l6ZTogMTQuMHB4O2NvbG9yOiAjMDAwMDAwOyI+0YLQtdC80LA8L2Rpdj48L3RkPjwvdHI+PC90YWJsZT48L2Rpdj48L2Rpdj48L3RkPjx0ZCB3aWR0aD0iMzQlIiBhbGlnbj0ibGVmdCI+PGRpdiBzdHlsZT0id2lkdGg6IDIzMC4wcHg7Zm9udC1mYW1pbHk6IOW+rui9r+mbhem7kTtiYWNrZ3JvdW5kOiAjZTgzNjQyO2JvcmRlci1yaWdodDogMS4wcHggI2UxZTBkZSBzb2xpZDtib3JkZXItdG9wOiAxLjBweCAjZTFlMGRlIHNvbGlkO2JvcmRlci1ib3R0b206IDEuMHB4ICNlMWUwZGUgc29saWQ7Ym9yZGVyLWxlZnQ6IDEuMHB4ICNlMWUwZGUgc29saWQ7cGFkZGluZzogNy4wcHg7bWFyZ2luOiBhdXRvOyI+PGEgaHJlZj0iaHR0cDovL2l0ZW0udGFvYmFvLmNvbS9pdGVtLmh0bT9pZD02MzE1NTUyMjI0MTkiIHRhcmdldD0iX2JsYW5rIiBzdHlsZT0iaGVpZ2h0OiAyMzAuMHB4O2Rpc3BsYXk6IGJsb2NrO21hcmdpbi1ib3R0b206IDUuMHB4O292ZXJmbG93OiBoaWRkZW47Ij48aW1nIHNyYz0iaHR0cHM6Ly9pbWcuYWxpY2RuLmNvbS9iYW8vdXBsb2FkZWQvaTMvMTM5NjYzOTQ5L08xQ04wMVd3cXhSZzFmMmdoVkJTaG9lXyEhMC1pdGVtX3BpYy5qcGdfMzEweDMxMC5qcGciIHdpZHRoPSIyMzAiIGhlaWdodD0iMjMwIiBib3JkZXI9IjAiPjwvYT48ZGl2Pjx0YWJsZSBzdHlsZT0ibWFyZ2luLWJvdHRvbTogNS4wcHg7IiBhbGlnbj0iY2VudGVyIiBib3JkZXJjb2xvcj0iI0ZGRkZGRiIgYm9yZGVyPSIwIiBjZWxscGFkZGluZz0iMCIgY2VsbHNwYWNpbmc9IjAiIHdpZHRoPSIyMzAiIGhlaWdodD0iMzIiPjx0cj48dGQgYmdjb2xvcj0iI2U4MzY0MiIgd2lkdGg9IjYwJSIgYWxpZ249ImxlZnQiPjxkaXYgc3R5bGU9InBhZGRpbmc6IDAuMHB4IDUuMHB4O292ZXJmbG93OiBoaWRkZW47dGV4dC1hbGlnbjogbGVmdDtmb250LXNpemU6IDEyLjBweDt0ZXh0LWRlY29yYXRpb246IGxpbmUtdGhyb3VnaDtjb2xvcjogI2ZmZmZmZjsiPtCm0LXQvdCwOiA3LDY8L2Rpdj48ZGl2IHN0eWxlPSJwYWRkaW5nLWxlZnQ6IDUuMHB4O292ZXJmbG93OiBoaWRkZW47dGV4dC1hbGlnbjogbGVmdDtmb250LXNpemU6IDEyLjBweDtjb2xvcjogI2ZmZmZmZjsiPtCi0LXQutGD0YnQsNGPINGG0LXQvdCwOiDvv6Ug77+lPGZvbnQgc3R5bGU9ImZvbnQtc2l6ZTogMjIuMHB4O2xpbmUtaGVpZ2h0OiAyMi4wcHg7Ij4gMy44PC9mb250PjwvZGl2PjwvdGQ+PHRkIHN0eWxlPSJwYWRkaW5nLWxlZnQ6IDEyLjBweDsiIHdpZHRoPSI0MCUiIGFsaWduPSJjZW50ZXIiIHZhbGlnbj0ibWlkZGxlIj48ZGl2IHN0eWxlPSJwYWRkaW5nOiAyLjBweDtsaW5lLWhlaWdodDogMjYuMHB4O2JhY2tncm91bmQtY29sb3I6ICNlODM2NDI7dGV4dC1hbGlnbjogY2VudGVyO292ZXJmbG93OiBoaWRkZW47Zm9udC1zaXplOiAxNC4wcHg7Y29sb3I6ICNmZmZmZmY7Ij7QrdGC0LjQutC10YLQutCwPC9kaXY+PGRpdiBzdHlsZT0iYm9yZGVyLXJpZ2h0OiAyLjBweCAjYzZjNmM2IHNvbGlkO2JvcmRlci1ib3R0b206IDIuMHB4ICNjNmM2YzYgc29saWQ7Ym9yZGVyLWxlZnQ6IDIuMHB4ICNjNmM2YzYgc29saWQ7bWFyZ2luOiAwIDQuMHB4O2JvcmRlci10b3A6IG5vbmU7dGV4dC1hbGlnbjogY2VudGVyO292ZXJmbG93OiBoaWRkZW47Zm9udC1zaXplOiAxNC4wcHg7Y29sb3I6ICMwMDAwMDA7Ij7RgtC10LzQsDwvZGl2PjwvdGQ+PC90cj48L3RhYmxlPjwvZGl2PjwvZGl2PjwvdGQ+PHRkIHdpZHRoPSIzMyUiIGFsaWduPSJsZWZ0Ij48ZGl2IHN0eWxlPSJ3aWR0aDogMjMwLjBweDtmb250LWZhbWlseTog5b6u6L2v6ZuF6buRO2JhY2tncm91bmQ6ICNlODM2NDI7Ym9yZGVyLXJpZ2h0OiAxLjBweCAjZTFlMGRlIHNvbGlkO2JvcmRlci10b3A6IDEuMHB4ICNlMWUwZGUgc29saWQ7Ym9yZGVyLWJvdHRvbTogMS4wcHggI2UxZTBkZSBzb2xpZDtib3JkZXItbGVmdDogMS4wcHggI2UxZTBkZSBzb2xpZDtwYWRkaW5nOiA3LjBweDttYXJnaW46IGF1dG87Ij48YSBocmVmPSJodHRwOi8vaXRlbS50YW9iYW8uY29tL2l0ZW0uaHRtP2lkPTYzMTU1ODMzMDMyOCIgdGFyZ2V0PSJfYmxhbmsiIHN0eWxlPSJoZWlnaHQ6IDIzMC4wcHg7ZGlzcGxheTogYmxvY2s7bWFyZ2luLWJvdHRvbTogNS4wcHg7b3ZlcmZsb3c6IGhpZGRlbjsiPjxpbWcgc3JjPSJodHRwczovL2ltZy5hbGljZG4uY29tL2Jhby91cGxvYWRlZC9pNC8xMzk2NjM5NDkvTzFDTjAxcWEwWVpLMWYyZ2hXMktUZzVfISEwLWl0ZW1fcGljLmpwZ18zMTB4MzEwLmpwZyIgd2lkdGg9IjIzMCIgaGVpZ2h0PSIyMzAiIGJvcmRlcj0iMCI+PC9hPjxkaXY+PHRhYmxlIHN0eWxlPSJtYXJnaW4tYm90dG9tOiA1LjBweDsiIGFsaWduPSJjZW50ZXIiIGJvcmRlcmNvbG9yPSIjRkZGRkZGIiBib3JkZXI9IjAiIGNlbGxwYWRkaW5nPSIwIiBjZWxsc3BhY2luZz0iMCIgd2lkdGg9IjIzMCIgaGVpZ2h0PSIzMiI+PHRyPjx0ZCBiZ2NvbG9yPSIjZTgzNjQyIiB3aWR0aD0iNjAlIiBhbGlnbj0ibGVmdCI+PGRpdiBzdHlsZT0icGFkZGluZzogMC4wcHggNS4wcHg7b3ZlcmZsb3c6IGhpZGRlbjt0ZXh0LWFsaWduOiBsZWZ0O2ZvbnQtc2l6ZTogMTIuMHB4O3RleHQtZGVjb3JhdGlvbjogbGluZS10aHJvdWdoO2NvbG9yOiAjZmZmZmZmOyI+0KbQtdC90LA6IDcsODwvZGl2PjxkaXYgc3R5bGU9InBhZGRpbmctbGVmdDogNS4wcHg7b3ZlcmZsb3c6IGhpZGRlbjt0ZXh0LWFsaWduOiBsZWZ0O2ZvbnQtc2l6ZTogMTIuMHB4O2NvbG9yOiAjZmZmZmZmOyI+0KLQtdC60YPRidCw0Y8g0YbQtdC90LA6IO+/pSDvv6U8Zm9udCBzdHlsZT0iZm9udC1zaXplOiAyMi4wcHg7bGluZS1oZWlnaHQ6IDIyLjBweDsiPiAzLjk8L2ZvbnQ+PC9kaXY+PC90ZD48dGQgc3R5bGU9InBhZGRpbmctbGVmdDogMTIuMHB4OyIgd2lkdGg9IjQwJSIgYWxpZ249ImNlbnRlciIgdmFsaWduPSJtaWRkbGUiPjxkaXYgc3R5bGU9InBhZGRpbmc6IDIuMHB4O2xpbmUtaGVpZ2h0OiAyNi4wcHg7YmFja2dyb3VuZC1jb2xvcjogI2U4MzY0Mjt0ZXh0LWFsaWduOiBjZW50ZXI7b3ZlcmZsb3c6IGhpZGRlbjtmb250LXNpemU6IDE0LjBweDtjb2xvcjogI2ZmZmZmZjsiPtCh0LvQtdC50YLQtSDQvNGL0LvRjNC90YPRjiDQutC+0YDQvtCx0LrRgzwvZGl2PjxkaXYgc3R5bGU9ImJvcmRlci1yaWdodDogMi4wcHggI2M2YzZjNiBzb2xpZDtib3JkZXItYm90dG9tOiAyLjBweCAjYzZjNmM2IHNvbGlkO2JvcmRlci1sZWZ0OiAyLjBweCAjYzZjNmM2IHNvbGlkO21hcmdpbjogMCA0LjBweDtib3JkZXItdG9wOiBub25lO3RleHQtYWxpZ246IGNlbnRlcjtvdmVyZmxvdzogaGlkZGVuO2ZvbnQtc2l6ZTogMTQuMHB4O2NvbG9yOiAjMDAwMDAwOyI+0YLQtdC80LA8L2Rpdj48L3RkPjwvdHI+PC90YWJsZT48L2Rpdj48L2Rpdj48L3RkPjwvdHI+PC90YWJsZT48L2Rpdj48L3RkPjwvdHI+PHRyPjx0ZCBoZWlnaHQ9IjAiIHN0eWxlPSJib3JkZXI6IDAuMHB4OyI+PGRpdiBzdHlsZT0ib3ZlcmZsb3c6IGhpZGRlbjsiPjxhIG5hbWU9InRwbF8zMTcwMjE3MTA0NzMwMzM0ODg5X29jZW50ZXIiPjxpbWcgd2lkdGg9IjEiIGhlaWdodD0iMSIgYm9yZGVyPSIwIiB1c2VtYXA9IiNvd2lrZV9jZW50ZXIzMTcwMjE3MTA0NzMwMzM0ODg5IiBzcmM9Imh0dHBzOi8vaW1nLmFsaWNkbi5jb20vaW1nZXh0cmEvaTIvNzQ4NzM5NTEyL1RCMlBNOEhnRlhYWFhiRlhwWFhYWFhYWFhYWC03NDg3Mzk1MTIuZ2lmP293aWtlX2NlbnRlcj0zMTcwMjE3MTA0NzMwMzM0ODg5Ij48L2E+PC9kaXY+PC90ZD48L3RyPjwvdGFibGU+PHAgc3R5bGU9Im92ZXJmbG93OiBoaWRkZW47cGFkZGluZzogMC4wcHg7bWFyZ2luOiAwLjBweCAwLjBweCAxMC4wcHggMC4wcHg7Ij48aW1nIHdpZHRoPSIxIiBoZWlnaHQ9IjEiIGJvcmRlcj0iMCIgdXNlbWFwPSIjb3dpa2VfMHUzMTcwMjE3MTA0NzMwMzM0ODg5IiBzcmM9Imh0dHBzOi8vaW1nLmFsaWNkbi5jb20vaW1nZXh0cmEvaTIvNzQ4NzM5NTEyL1RCMlBNOEhnRlhYWFhiRlhwWFhYWFhYWFhYWC03NDg3Mzk1MTIuZ2lmP293aWtlXzBpPTMxNzAyMTcxMDQ3MzAzMzQ4ODkiPjwvcD48dGFibGUgc3R5bGU9ImJvcmRlci1yaWdodDogI2JlYmViZSAxLjBweCBzb2xpZDtib3JkZXItdG9wOiAjYmViZWJlIDEuMHB4IHNvbGlkO2JvcmRlci1sZWZ0OiAjYmViZWJlIDEuMHB4IHNvbGlkO2JvcmRlci1ib3R0b206ICNiZWJlYmUgMS4wcHggc29saWQ7IiB3aWR0aD0iNzQ4Ij48dHI+PHRkIGFsaWduPSJjZW50ZXIiIGNvbHNwYW49IjIiPjxwIHN0eWxlPSJtYXJnaW46IDAgMCAwIDA7b3ZlcmZsb3c6IGhpZGRlbjsiPjxpbWcgYWx0PSIiIHNyYz0iaHR0cHM6Ly9pbWcuYWxpY2RuLmNvbS9pbWdleHRyYS9pMi8xNjAxNjU2Ni9UQjJPSjNsWFZYWFhYY2VYWFhYWFhYWFhYWFgtMTYwMTY1NjYucG5nP3A9dGJrX2RoX3N0YXJ0c19kZXRhaWxfMTU1MDcxNyI+PC9wPjxkaXYgY2xhc3M9ImRtX21vZHVsZSIgZGF0YS1pZD0iMTU1MDcxNyIgZGF0YS10aXRsZT0i5Z+65pys5L+h5oGvIiBpZD0iaWRzLW1vZHVsZS0xNTUwNzE3IiBzdHlsZT0ibWFyZ2luOiAwIDAgMCAwO292ZXJmbG93OiBoaWRkZW47Ij4mYW1wO25ic3A7PC9kaXY+PHAgc3R5bGU9Im1hcmdpbjogMCAwIDAgMDtvdmVyZmxvdzogaGlkZGVuOyI+PGltZyBhbHQ9IiIgc3JjPSJodHRwczovL2ltZy5hbGljZG4uY29tL2ltZ2V4dHJhL2kyLzE2MDE2NTY2L1RCMk9KM2xYVlhYWFhjZVhYWFhYWFhYWFhYWC0xNjAxNjU2Ni5wbmc/cD10YmtfZGhfZW5kX2RldGFpbF8xNTUwNzE3Ij48L3A+PGltZyBib3JkZXI9IjAiIGFsdD0iIiBzcmM9Imh0dHBzOi8vaW1nLmFsaWNkbi5jb20vaW1nZXh0cmEvaTMvMTM5NjYzOTQ5L1QyLkpKVFhnNGNYWFhYWFhYWF8hITEzOTY2Mzk0OS5qcGciPjwvdGQ+PC90cj48dHI+PHRkIGFsaWduPSJjZW50ZXIiIGNvbHNwYW49IjIiPjxpbWcgYm9yZGVyPSIwIiBhbHQ9IiIgc3JjPSJodHRwczovL2ltZy5hbGljZG4uY29tL2ltZ2V4dHJhL2k0LzEzOTY2Mzk0OS9UQjJBZE9NZWRzbXlLSmpTWkZ2WFhjRS5GWGFfISExMzk2NjM5NDkuanBnIj48L3RkPjwvdHI+PHRyPjx0ZCBhbGlnbj0iY2VudGVyIiB3aWR0aD0iMzIwIj48aW1nIGJvcmRlcj0iMCIgaGVpZ2h0PSIzMTAiIHdpZHRoPSIzMTAiIGFsdD0iIiBzcmM9Imh0dHBzOi8vaW1nLmFsaWNkbi5jb20vaW1nZXh0cmEvaTQvMTM5NjYzOTQ5L08xQ04wMTFmMmdXTjNmVmxtdlhUTV8hITEzOTY2Mzk0OS5qcGciPjwvdGQ+PHRkIGFsaWduPSJjZW50ZXIiIHdpZHRoPSI0MDAiPjx0YWJsZSBib3JkZXI9IjAiIGNlbGxwYWRkaW5nPSIwIiBjZWxsc3BhY2luZz0iMCIgaGVpZ2h0PSIzMDEiIHdpZHRoPSI0MDAiPjx0cj48dGQgYWxpZ249ImxlZnQiIGJnY29sb3I9IiNmMmYyZjIiIGhlaWdodD0iMjUiIHZhbGlnbj0iY2VudGVyIiB3aWR0aD0iMzY4Ij48aW1nIGFsdD0i0J7RgdC90L7QstC90LDRjyDQuNC90YTQvtGA0LzQsNGG0LjRjyIgYm9yZGVyPSIwIiBzcmM9Imh0dHBzOi8vaW1nLmFsaWNkbi5jb20vaW1nZXh0cmEvaTEvMTM5NjYzOTQ5L1QySUU5UlhlOGFYWFhYWFhYWF8hITEzOTY2Mzk0OS5qcGciPjwvdGQ+PC90cj48dHI+PHRkIGhlaWdodD0iMTEiIHZhbGlnbj0iYm90dG9tIj48ZGl2PiZhbXA7bmJzcDsmYW1wO25ic3A7PC9kaXY+PC90ZD48L3RyPjx0cj48dGQgaGVpZ2h0PSIyNjAiIHZhbGlnbj0iYm90dG9tIj48dGFibGUgYWxpZ249ImNlbnRlciIgYm9yZGVyPSIwIiBjZWxscGFkZGluZz0iMCIgY2VsbHNwYWNpbmc9IjAiIGhlaWdodD0iMjQ4IiB3aWR0aD0iMzkwIj48dHI+PHRkIGFsaWduPSJjZW50ZXIiIGhlaWdodD0iaGVpZ2h0IiB3aWR0aD0iMTgiPjxpbWcgYm9yZGVyPSIwIiBoZWlnaHQ9IjE2IiB3aWR0aD0iMTYiIGFsdD0iIiBzcmM9Imh0dHBzOi8vaW1nLmFsaWNkbi5jb20vaW1nZXh0cmEvaTEvMTM5NjYzOTQ5L1QyOFJPV1hlWGFYWFhYWFhYWF8hITEzOTY2Mzk0OS5naWYiPjwvdGQ+PHRkIGFsaWduPSJsZWZ0IiBoZWlnaHQ9IjM1IiB2YWxpZ249ImNlbnRlciI+0LjQvNGPOjwvdGQ+PHRkIGFsaWduPSJsZWZ0IiBoZWlnaHQ9IjM1IiB2YWxpZ249ImNlbnRlciI+0JDRgNC+0LzQsNGC0L3QsNGPINGD0LHQvtGA0LrQsCDRgtGD0LDQu9C10YLQsCDQotGD0LDQu9C10YLQvdC+0LUg0YHQvtC60YDQvtCy0LjRidC1INGB0LjQvdC10LUg0L/Rg9C30YvRgNGMPC90ZD48L3RyPjx0cj48dGQgYWxpZ249ImNlbnRlciIgaGVpZ2h0PSIzNSIgd2lkdGg9IjE4Ij48aW1nIGJvcmRlcj0iMCIgaGVpZ2h0PSIxNiIgd2lkdGg9IjE2IiBhbHQ9IiIgc3JjPSJodHRwczovL2ltZy5hbGljZG4uY29tL2ltZ2V4dHJhL2kxLzEzOTY2Mzk0OS9UMjhST1dYZVhhWFhYWFhYWFhfISExMzk2NjM5NDkuZ2lmIj48L3RkPjx0ZCBhbGlnbj0ibGVmdCIgaGVpZ2h0PSIzNSIgdmFsaWduPSJjZW50ZXIiPtGA0LDQt9C80LXRgDo8L3RkPjx0ZCBhbGlnbj0ibGVmdCIgaGVpZ2h0PSIzNSIgdmFsaWduPSJjZW50ZXIiPjUwINCz0YDQsNC80LwsIDIwINC80LDRgdGB0L7QstGL0YUg0L/QvtGB0YLQsNCy0YnQuNC60L7Qsi48L3RkPjwvdHI+PHRyPjx0ZCBhbGlnbj0iY2VudGVyIiBoZWlnaHQ9IjM1IiB3aWR0aD0iMTgiPjxpbWcgYm9yZGVyPSIwIiBoZWlnaHQ9IjE2IiB3aWR0aD0iMTYiIGFsdD0iIiBzcmM9Imh0dHBzOi8vaW1nLmFsaWNkbi5jb20vaW1nZXh0cmEvaTEvMTM5NjYzOTQ5L1QyOFJPV1hlWGFYWFhYWFhYWF8hITEzOTY2Mzk0OS5naWYiPjwvdGQ+PHRkIGFsaWduPSJsZWZ0IiBoZWlnaHQ9IjM1IiB2YWxpZ249ImNlbnRlciI+0JzQsNGC0LXRgNC40LDQuzo8L3RkPjx0ZCBhbGlnbj0ibGVmdCIgaGVpZ2h0PSIzNSIgdmFsaWduPSJjZW50ZXIiPtCQ0LrRgtC40LLQvdC+0LUg0YfQuNGB0YLRj9GJ0LXQtSDRgdGA0LXQtNGB0YLQstC+K9GB0YLQtdGA0LjQu9C40LfQsNGC0L7RgCvQsNGA0L7QvNCw0YLQuNGH0LXRgdC60LjQuSDQsNCz0LXQvdGCK9C/0L7Qu9C40LzQtdGA0L3Ri9C5INC/0L7Qu9C40LzQtdGAPC90ZD48L3RyPjx0cj48dGQgYWxpZ249ImNlbnRlciIgaGVpZ2h0PSIzNSIgd2lkdGg9IjE4Ij48aW1nIGJvcmRlcj0iMCIgaGVpZ2h0PSIxNiIgd2lkdGg9IjE2IiBhbHQ9IiIgc3JjPSJodHRwczovL2ltZy5hbGljZG4uY29tL2ltZ2V4dHJhL2kxLzEzOTY2Mzk0OS9UMjhST1dYZVhhWFhYWFhYWFhfISExMzk2NjM5NDkuZ2lmIj48L3RkPjx0ZCBhbGlnbj0ibGVmdCIgaGVpZ2h0PSIzNSIgdmFsaWduPSJjZW50ZXIiPtGG0LLQtdGCOjwvdGQ+PHRkIGFsaWduPSJsZWZ0IiBoZWlnaHQ9IjM1IiB2YWxpZ249ImNlbnRlciI+0YHQuNC90LjQuTwvdGQ+PC90cj48dHI+PHRkIGFsaWduPSJjZW50ZXIiIGhlaWdodD0iMzAiPjxpbWcgYm9yZGVyPSIwIiBoZWlnaHQ9IjE2IiB3aWR0aD0iMTYiIGFsdD0iIiBzcmM9Imh0dHBzOi8vaW1nLmFsaWNkbi5jb20vaW1nZXh0cmEvaTEvMTM5NjYzOTQ5L1QyOFJPV1hlWGFYWFhYWFhYWF8hITEzOTY2Mzk0OS5naWYiPjwvdGQ+PHRkIGFsaWduPSJsZWZ0IiBoZWlnaHQ9IjMwIiB2YWxpZ249ImNlbnRlciIgd2lkdGg9IjQyIj7QktCy0LXQtNC10L3QuNC1OjwvdGQ+PHRkIGFsaWduPSJsZWZ0IiBoZWlnaHQ9IjcxIiByb3dzcGFuPSIyIiB2YWxpZ249InRvcCIgd2lkdGg9IjMzMCI+0KLRg9Cw0LvQtdGCINC00L7QvNCwINC70LXQs9C60L4g0YDQsNC30LLQvtC00LjRgtGMINCx0LDQutGC0LXRgNC40LkuINCS0L3Rg9GC0YDQtdC90L3Rj9GPINGB0YLQtdC90LAg0YLRg9Cw0LvQtdGC0LAsINC60L7RgtC+0YDQsNGPINGC0L7Qu9GM0LrQviDRh9GC0L4g0LfQsNC60L7QvdGH0LjQu9CwINCy0L7QtNCwLCDQstGB0LUg0LXRidC1INC40LzQtdC10YIg0LzQvdC+0LPQviDQsdCw0LrRgtC10YDQuNC5LCDQutC+0YLQvtGA0YvQtSDRgdC10YDRjNC10LfQvdC+INCy0LvQuNGP0Y7RgiDQvdCwINC30LTQvtGA0L7QstGM0LUg0YHQtdC80YzQuC7QrdGC0L7RgiDQv9GA0L7QtNGD0LrRgiDQuNC80LXQtdGCINGN0YTRhNC10LrRgiDQuNC90LPQuNCx0LjRgNC+0LLQsNC90LjRjyDQsdCw0LrRgtC10YDQuNC5INC4INC00LXQu9Cw0LXRgiDRgtGD0LDQu9C10YIg0LHQvtC70LXQtSDQs9C40LPQuNC10L3QuNGH0L3Ri9C8LjwvdGQ+PC90cj48dHI+PHRkIGhlaWdodD0iNDUiPiZhbXA7bmJzcDs8L3RkPjx0ZCBhbGlnbj0ibGVmdCIgaGVpZ2h0PSI0NSIgdmFsaWduPSJ0b3AiIHdpZHRoPSI0MiI+JmFtcDtuYnNwOzwvdGQ+PC90cj48L3RhYmxlPjwvdGQ+PC90cj48L3RhYmxlPjwvdGQ+PC90cj48dHI+PHRkIGFsaWduPSJjZW50ZXIiIGNvbHNwYW49IjIiIGhlaWdodD0iNSI+JmFtcDtuYnNwOzwvdGQ+PC90cj48dHI+PHRkIGFsaWduPSJjZW50ZXIiIGNvbHNwYW49IjIiPjxwIHN0eWxlPSJtYXJnaW46IDAgMCAwIDA7b3ZlcmZsb3c6IGhpZGRlbjsiPjxpbWcgYWx0PSIiIHNyYz0iaHR0cHM6Ly9pbWcuYWxpY2RuLmNvbS9pbWdleHRyYS9pMi8xNjAxNjU2Ni9UQjJPSjNsWFZYWFhYY2VYWFhYWFhYWFhYWFgtMTYwMTY1NjYucG5nP3A9dGJrX2RoX3N0YXJ0c19kZXRhaWxfNTcwOTE5OSI+PC9wPjxkaXYgY2xhc3M9ImRtX21vZHVsZSIgZGF0YS1pZD0iNTcwOTE5OSIgZGF0YS10aXRsZT0i6K+m57uG6K+05piOIiBpZD0iaWRzLW1vZHVsZS01NzA5MTk5IiBzdHlsZT0ibWFyZ2luOiAwIDAgMCAwO292ZXJmbG93OiBoaWRkZW47Ij4mYW1wO25ic3A7PC9kaXY+PHAgc3R5bGU9Im1hcmdpbjogMCAwIDAgMDtvdmVyZmxvdzogaGlkZGVuOyI+PGltZyBhbHQ9IiIgc3JjPSJodHRwczovL2ltZy5hbGljZG4uY29tL2ltZ2V4dHJhL2kyLzE2MDE2NTY2L1RCMk9KM2xYVlhYWFhjZVhYWFhYWFhYWFhYWC0xNjAxNjU2Ni5wbmc/cD10YmtfZGhfZW5kX2RldGFpbF81NzA5MTk5Ij48L3A+PGltZyBhbGlnbj0ibWlkZGxlIiBib3JkZXI9IjAiIGFsdD0iIiBzcmM9Imh0dHBzOi8vaW1nLmFsaWNkbi5jb20vaW1nZXh0cmEvaTMvMTM5NjYzOTQ5L1RCMk42cUJlZEFteUtKalNaRkdYWGIuZkZYYV8hITEzOTY2Mzk0OS5qcGciPjwvdGQ+PC90cj48dHI+PHRkIGFsaWduPSJjZW50ZXIiIGNvbHNwYW49IjIiPjx0YWJsZSBhbGlnbj0iY2VudGVyIiBib3JkZXI9IjAiIGNlbGxwYWRkaW5nPSIwIiBjZWxsc3BhY2luZz0iMCIgd2lkdGg9IjY4MCI+PHRyPjx0ZCBhbGlnbj0iY2VudGVyIj48dGFibGUgYWxpZ249ImNlbnRlciIgYmdjb2xvcj0iI2Q5ZDlkOSIgYm9yZGVyPSIwIiBjZWxscGFkZGluZz0iMyIgY2VsbHNwYWNpbmc9IjEiIGhlaWdodD0iMTExIiB3aWR0aD0iNjYwIj48dHI+PHRkIGFsaWduPSJsZWZ0IiBiZ2NvbG9yPSIjZmZmZmZmIiBoZWlnaHQ9IjIwIiB2YWxpZ249ImNlbnRlciIgd2lkdGg9Ijk4Ij48aW1nIGJvcmRlcj0iMCIgaGVpZ2h0PSIxNiIgd2lkdGg9IjE2IiBhbHQ9IiIgc3JjPSJodHRwczovL2ltZy5hbGljZG4uY29tL2ltZ2V4dHJhL2kxLzEzOTY2Mzk0OS9UMjhST1dYZVhhWFhYWFhYWFhfISExMzk2NjM5NDkuZ2lmIj7QnNC10YDRiyDQv9GA0LXQtNC+0YHRgtC+0YDQvtC20L3QvtGB0YLQuDo8L3RkPjx0ZCBhbGlnbj0ibGVmdCIgYmdjb2xvcj0iI2ZmZmZmZiIgaGVpZ2h0PSIyMCIgd2lkdGg9IjU1MCI+PHN0cm9uZz4yMCDQndC10LfQsNCy0LjRgdC40LzQsNGPINGD0L/QsNC60L7QstC60LAu0JTQu9C40L3QsCDQuNGB0L/QvtC70YzQt9C+0LLQsNC90LjRjyDRgtGD0LDQu9C10YLQvdC+0LPQviDQtNGD0YXQsCDRgdCy0Y/Qt9Cw0L3QsCDRgSDRgNCw0LfQvNC10YDQvtC8INGC0YPQsNC70LXRgtC90L7QuSDQstC+0LTRiyDQsiDQtNC+0LzQsNGI0L3QuNGFINGD0YHQu9C+0LLQuNGP0YUg0Lgg0LrQvtC70LjRh9C10YHRgtCy0L7QvCDQt9Cw0L/QvtC70L3QtdC90L3QvtC5INCy0L7QtNGLLiDQktGL0YHQvtC60LDRjyDRgtC10LzQv9C10YDQsNGC0YPRgNCwINCy0L7QtNGLINC70LXRgtC+0Lwg0LHRg9C00LXRgiDQutC+0YDQvtGH0LUg0LfQuNC80Ysu0J3QsNGH0L3QuNGC0LUg0YEg0LTQsNC70YzQvdC10LPQviDQutC+0L3RhtCwINGC0YPQsNC70LXRgtC90L7QuSDRgNC10LfQtdGA0LLRg9Cw0YDQsCDQstC+0LTRiyDQsiDQuCDQstGL0YXQvtC00LUg0LjQtyDRgNC+0LfQtdGC0LrQuCDQstC+0LTRiy4g0J/QvtC20LDQu9GD0LnRgdGC0LAsINC90LUg0YHRgNGL0LLQsNC50YLQtSDQstC90LXRiNC90Y7RjiDQstC+0LTRgyAt0YHQvtGB0YPRidC10YHRgtCy0YPQtdC80LDRjyDQvNC10LzQsdGA0LDQvdCwLiDQn9GA0L7RgdGC0L4g0L/QvtC80LXRgdGC0LjRgtC1INC10LUg0L3QsNC/0YDRj9C80YPRji48L3N0cm9uZz48L3RkPjwvdHI+PHRyPjx0ZCBhbGlnbj0ibGVmdCIgYmdjb2xvcj0iI2ZmZmZmZiIgaGVpZ2h0PSIyMCIgdmFsaWduPSJjZW50ZXIiIHdpZHRoPSI5OCI+PGltZyBib3JkZXI9IjAiIGhlaWdodD0iMTYiIHdpZHRoPSIxNiIgYWx0PSIiIHNyYz0iaHR0cHM6Ly9pbWcuYWxpY2RuLmNvbS9pbWdleHRyYS9pMS8xMzk2NjM5NDkvVDI4Uk9XWGVYYVhYWFhYWFhYXyEhMTM5NjYzOTQ5LmdpZiI+0J/QvtC00YDQvtCx0L3QvtC1INC+0L/QuNGB0LDQvdC40LU6PC90ZD48dGQgYWxpZ249ImxlZnQiIGJnY29sb3I9IiNmZmZmZmYiIGhlaWdodD0iMjAiIHdpZHRoPSI1NTAiPtCf0YDQvtC00YPQutGCINC40YHQv9C+0LvRjNC30YPQtdGCINCy0L7QtNC90YPRjiDQvNC10LzQsdGA0LDQvdGDLiDQrdGC0L4g0L3QtSDQt9Cw0YHRgtCw0LLQu9GP0LXRgiDRgtGD0LDQu9C10YIg0LHQu9C+0LrQuNGA0L7QstCw0YLRjCwg0L3QtSDQv9GA0LjQu9C40L/QsNGPINGA0YPQui7QndCw0YPRh9C90YvQtSDRhNC+0YDQvNGD0LvRiywg0Y3RhNGE0LXQutGC0LjQstC90L4g0YfQuNGB0YLQutCwINC80L7Rh9C4LCDQvdCw0LLQvtC3LCDQvNCw0YHRiNGC0LDQsSwg0LzQsNGB0LvQviDQuCDQtNGA0YPQs9GD0Y4g0LPRgNGP0LfRjCDQuCDQvdC1INC/0L7QstGA0LXQtNGP0YIg0L/QvtCy0LXRgNGF0L3QvtGB0YLQuCDRgtGD0LDQu9C10YLQsC7Qn9GA0L7Rh9C90LDRjywg0LTQvtC70LPQvtCy0LXRh9C90L7RgdGC0YwsINGB0LzQtdGI0LDQvdC90LDRjyDRgSDRgNCw0LfQu9C40YfQvdGL0LzQuCDQv9GA0L7QvNGL0LLQutCw0LzQuCDQuCDQsNGA0L7QvNCw0YLQvtC8LCDQuNC90LPRgNC10LTQuNC10L3RgtCw0LzQuCDRgdGC0LXRgNC40LvQuNC30LDRhtC40LgsINC80L3QvtCz0L7RjdGE0YTQtdC60YLQuNCy0L3Ri9C8LCDQv9C+0LvQvdC+0YHRgtGM0Y4g0LDQstGC0L7QvNCw0YLQuNGH0LXRgdC60LjQvC48L3RkPjwvdHI+PC90YWJsZT48L3RkPjwvdHI+PC90YWJsZT48YnI+PGltZyBhbHQ9ImFsdCIgYm9yZGVyPSIwIiBzcmM9Imh0dHBzOi8vaW1nLmFsaWNkbi5jb20vaW1nZXh0cmEvaTEvMTM5NjYzOTQ5L08xQ04wMTFmMmdXU3J6eUp4MVNRZl8hITEzOTY2Mzk0OS5qcGciPjxicj48aW1nIGFsdD0iYWx0IiBib3JkZXI9IjAiIHNyYz0iaHR0cHM6Ly9pbWcuYWxpY2RuLmNvbS9pbWdleHRyYS9pMi8xMzk2NjM5NDkvTzFDTjAxMWYyZ1dUS205cXdDNHFxXyEhMTM5NjYzOTQ5LmpwZyI+PGJyPjxpbWcgYWx0PSJhbHQiIGJvcmRlcj0iMCIgc3JjPSJodHRwczovL2ltZy5hbGljZG4uY29tL2ltZ2V4dHJhL2kzLzEzOTY2Mzk0OS9PMUNOMDExZjJnV1RkZ0ZmV3lFeWlfISExMzk2NjM5NDkuanBnIj48YnI+PHAgc3R5bGU9Im1hcmdpbjogMCAwIDAgMDtvdmVyZmxvdzogaGlkZGVuOyI+PGltZyBhbHQ9IiIgc3JjPSJodHRwczovL2ltZy5hbGljZG4uY29tL2ltZ2V4dHJhL2kyLzE2MDE2NTY2L1RCMk9KM2xYVlhYWFhjZVhYWFhYWFhYWFhYWC0xNjAxNjU2Ni5wbmc/cD10YmtfZGhfc3RhcnRzX2RldGFpbF8zNjMxNDAxIj48L3A+PGRpdiBjbGFzcz0iZG1fbW9kdWxlIiBkYXRhLWlkPSIzNjMxNDAxIiBkYXRhLXRpdGxlPSLlrp7mi43lsZXnpLoiIGlkPSJpZHMtbW9kdWxlLTM2MzE0MDEiIHN0eWxlPSJtYXJnaW46IDAgMCAwIDA7b3ZlcmZsb3c6IGhpZGRlbjsiPiZhbXA7bmJzcDs8L2Rpdj48cCBzdHlsZT0ibWFyZ2luOiAwIDAgMCAwO292ZXJmbG93OiBoaWRkZW47Ij48aW1nIGFsdD0iIiBzcmM9Imh0dHBzOi8vaW1nLmFsaWNkbi5jb20vaW1nZXh0cmEvaTIvMTYwMTY1NjYvVEIyT0ozbFhWWFhYWGNlWFhYWFhYWFhYWFhYLTE2MDE2NTY2LnBuZz9wPXRia19kaF9lbmRfZGV0YWlsXzM2MzE0MDEiPjwvcD48aW1nIGFsdD0iYWx0IiBib3JkZXI9IjAiIHNyYz0iaHR0cHM6Ly9pbWcuYWxpY2RuLmNvbS9pbWdleHRyYS9pNC8xMzk2NjM5NDkvTzFDTjAxMWYyZ1dUS21wT0VYTjBaXyEhMTM5NjYzOTQ5LmpwZyI+PGJyPjxpbWcgYWx0PSJhbHQiIGJvcmRlcj0iMCIgc3JjPSJodHRwczovL2ltZy5hbGljZG4uY29tL2ltZ2V4dHJhL2kxLzEzOTY2Mzk0OS9PMUNOMDExZjJnV1VGTkRFdFhUU3dfISExMzk2NjM5NDkuanBnIj48YnI+PGltZyBhbHQ9ImFsdCIgYm9yZGVyPSIwIiBzcmM9Imh0dHBzOi8vaW1nLmFsaWNkbi5jb20vaW1nZXh0cmEvaTQvMTM5NjYzOTQ5L08xQ04wMTFmMmdXVFMzVE1nZkVIUV8hITEzOTY2Mzk0OS5qcGciPjxicj48cCBzdHlsZT0ibWFyZ2luOiAwIDAgMCAwO292ZXJmbG93OiBoaWRkZW47Ij48aW1nIGFsdD0iIiBzcmM9Imh0dHBzOi8vaW1nLmFsaWNkbi5jb20vaW1nZXh0cmEvaTIvMTYwMTY1NjYvVEIyT0ozbFhWWFhYWGNlWFhYWFhYWFhYWFhYLTE2MDE2NTY2LnBuZz9wPXRia19kaF9zdGFydHNfZGV0YWlsXzE2NTU5MzMiPjwvcD48ZGl2IGNsYXNzPSJkbV9tb2R1bGUiIGRhdGEtaWQ9IjE2NTU5MzMiIGRhdGEtdGl0bGU9IuS9v+eUqOaViOaenCIgaWQ9Imlkcy1tb2R1bGUtMTY1NTkzMyIgc3R5bGU9Im1hcmdpbjogMCAwIDAgMDtvdmVyZmxvdzogaGlkZGVuOyI+JmFtcDtuYnNwOzwvZGl2PjxwIHN0eWxlPSJtYXJnaW46IDAgMCAwIDA7b3ZlcmZsb3c6IGhpZGRlbjsiPjxpbWcgYWx0PSIiIHNyYz0iaHR0cHM6Ly9pbWcuYWxpY2RuLmNvbS9pbWdleHRyYS9pMi8xNjAxNjU2Ni9UQjJPSjNsWFZYWFhYY2VYWFhYWFhYWFhYWFgtMTYwMTY1NjYucG5nP3A9dGJrX2RoX2VuZF9kZXRhaWxfMTY1NTkzMyI+PC9wPjxpbWcgYWx0PSJhbHQiIGJvcmRlcj0iMCIgc3JjPSJodHRwczovL2ltZy5hbGljZG4uY29tL2ltZ2V4dHJhL2k0LzEzOTY2Mzk0OS9PMUNOMDExZjJnV1RLbVluQ3hhazJfISExMzk2NjM5NDkuanBnIj48YnI+PGltZyBhbHQ9ImFsdCIgYm9yZGVyPSIwIiBzcmM9Imh0dHBzOi8vaW1nLmFsaWNkbi5jb20vaW1nZXh0cmEvaTQvMTM5NjYzOTQ5L08xQ04wMTFmMmdXVHFUUzdpRVZiTV8hITEzOTY2Mzk0OS5qcGciPjxicj48aW1nIGFsdD0iYWx0IiBib3JkZXI9IjAiIHNyYz0iaHR0cHM6Ly9pbWcuYWxpY2RuLmNvbS9pbWdleHRyYS9pNC8xMzk2NjM5NDkvTzFDTjAxMWYyZ1dUUzRvVVBUMjB5XyEhMTM5NjYzOTQ5LmpwZyI+PGJyPjxpbWcgYWx0PSJhbHQiIGJvcmRlcj0iMCIgc3JjPSJodHRwczovL2ltZy5hbGljZG4uY29tL2ltZ2V4dHJhL2kzLzEzOTY2Mzk0OS9PMUNOMDExZjJnV1VRZEhLQmlkQW9fISExMzk2NjM5NDkuanBnIj48cCBzdHlsZT0ibWFyZ2luOiAwIDAgMCAwO292ZXJmbG93OiBoaWRkZW47Ij48aW1nIGFsdD0iIiBzcmM9Imh0dHBzOi8vaW1nLmFsaWNkbi5jb20vaW1nZXh0cmEvaTIvMTYwMTY1NjYvVEIyT0ozbFhWWFhYWGNlWFhYWFhYWFhYWFhYLTE2MDE2NTY2LnBuZz9wPXRia19kaF9zdGFydHNfZGV0YWlsXzI4ODkwNjQiPjwvcD48ZGl2IGNsYXNzPSJkbV9tb2R1bGUiIGRhdGEtaWQ9IjI4ODkwNjQiIGRhdGEtdGl0bGU9IueMnOaCqOWWnOasoiIgaWQ9Imlkcy1tb2R1bGUtMjg4OTA2NCIgc3R5bGU9Im1hcmdpbjogMCAwIDAgMDtvdmVyZmxvdzogaGlkZGVuOyI+JmFtcDtuYnNwOzwvZGl2PjxwIHN0eWxlPSJtYXJnaW46IDAgMCAwIDA7b3ZlcmZsb3c6IGhpZGRlbjsiPjxpbWcgYWx0PSIiIHNyYz0iaHR0cHM6Ly9pbWcuYWxpY2RuLmNvbS9pbWdleHRyYS9pMi8xNjAxNjU2Ni9UQjJPSjNsWFZYWFhYY2VYWFhYWFhYWFhYWFgtMTYwMTY1NjYucG5nP3A9dGJrX2RoX2VuZF9kZXRhaWxfMjg4OTA2NCI+PC9wPjwvdGQ+PC90cj48L3RhYmxlPjxwPiZhbXA7bmJzcDs8L3A+PHRhYmxlIGFsaWduPSJhYmxkZXNjbW9kX3RiIiBiYWNrZ3JvdW5kPSJodHRwczovL2ltZy5hbGljZG4uY29tL2ltZ2V4dHJhL2k0LzIwODQxMzk4L1RCMkR4ZDJnRlhYWFhYWFhwWFhYWFhYWFhYWC0yMDg0MTM5OC5wbmciPjx0cj48dGQ+PGRpdiBzdHlsZT0ibWluLXdpZHRoOiA3NTAuMHB4O21heC13aWR0aDogOTUwLjBweDsiPjxwPjxpbWcgc3JjPSJodHRwczovL2ltZy5hbGljZG4uY29tL2ltZ2V4dHJhL2kzLzEzOTY2Mzk0OS9UQjIyV3BZbXdSa3B1Rmp5MXplWFhjLjZGWGFfISExMzk2NjM5NDkuanBnIj48L3A+PC9kaXY+PC90ZD48L3RyPjx0cj48dGQ+PGRpdiBzdHlsZT0ibWluLXdpZHRoOiA3NTAuMHB4O21heC13aWR0aDogOTUwLjBweDsiPjx0YWJsZSBhbGlnbj0iY2VudGVyIiB3aWR0aD0iNzUwIiBib3JkZXI9IjAiIGNlbGxzcGFjaW5nPSIwIiBjZWxscGFkZGluZz0iMCI+PHRyPjx0ZCBzdHlsZT0id2lkdGg6IDEwMC4wJTsiPjx0YWJsZSBib3JkZXI9IjAiIGNlbGxzcGFjaW5nPSIwIiBjZWxscGFkZGluZz0iMCIgc3R5bGU9IndpZHRoOiA3NDYuMHB4O2JvcmRlci1jb2xsYXBzZTogY29sbGFwc2U7Ym9yZGVyLXNwYWNpbmc6IDA7Ym9yZGVyLWxlZnQ6IDEuMHB4IHNvbGlkICNjMGJlYmY7Ym9yZGVyLXRvcDogMS4wcHggc29saWQgI2MwYmViZjttYXJnaW46IDAgYXV0bztmb250OiAxMi4wcHggbWljcm9zb2Z0IHlhaGVpOyI+PHRyPjx0ZCBzdHlsZT0iYm9yZGVyLXJpZ2h0OiAxLjBweCBzb2xpZCAjYzBiZWJmO2JvcmRlci1ib3R0b206IDEuMHB4IHNvbGlkICNjMGJlYmY7d2lkdGg6IDE4Ni4wcHg7cGFkZGluZy1ib3R0b206IDUuMHB4OyI+PHRhYmxlIGNlbGxzcGFjaW5nPSIwIiBjZWxscGFkZGluZz0iMCIgc3R5bGU9IndpZHRoOiAxMDAuMCU7Ym9yZGVyOiAwO2JhY2tncm91bmQtY29sb3I6ICNmZmZmZmY7Ij48dHI+PHRkPjxkaXYgc3R5bGU9ImhlaWdodDogMjUuMHB4O2xpbmUtaGVpZ2h0OiAzMC4wcHg7b3ZlcmZsb3c6IGhpZGRlbjt0ZXh0LWFsaWduOiBjZW50ZXI7d2hpdGUtc3BhY2U6IG5vd3JhcDsiPjxhIHN0eWxlPSJkaXNwbGF5OiBpbmxpbmUtYmxvY2s7Y29sb3I6ICNmZjAwMDA7Zm9udC1zaXplOiAxNC4wcHg7Zm9udC13ZWlnaHQ6IGJvbGQ7cGFkZGluZy1yaWdodDogMTAuMHB4O3RleHQtZGVjb3JhdGlvbjogbm9uZTsiIHRhcmdldD0iX2JsYW5rIiBocmVmPSJodHRwOi8vaXRlbS50YW9iYW8uY29tL2l0ZW0uaHRtP2lkPTYyMTcwNjQ5NjU1NyI+0K8g0LTRg9C80LDRjiwg0YLQtdCx0LUg0L/QvtC90YDQsNCy0LjRgtGB0Y88L2E+PC9kaXY+PC90ZD48L3RyPjx0cj48dGQgc3R5bGU9IndpZHRoOiAxODAuMHB4O2hlaWdodDogMTgwLjBweDt0ZXh0LWFsaWduOiBjZW50ZXI7Ij48YSBzdHlsZT0idGV4dC1kZWNvcmF0aW9uOiBub25lO3ZlcnRpY2FsLWFsaWduOiBtaWRkbGU7IiB0YXJnZXQ9Il9ibGFuayIgaHJlZj0iaHR0cDovL2l0ZW0udGFvYmFvLmNvbS9pdGVtLmh0bT9pZD02MjE3MDY0OTY1NTciPjxpbWcgYWx0PSIiIHNyYz0iaHR0cHM6Ly9pbWcuYWxpY2RuLmNvbS9iYW8vdXBsb2FkZWQvaTEvMTM5NjYzOTQ5L08xQ04wMXlaZTNHcjFmMmdmbXZnUHVtXyEhMC1pdGVtX3BpYy5qcGdfMTcweDE3MC5qcGciPjwvYT48L3RkPjwvdHI+PHRyPjx0ZD48cCBzdHlsZT0icGFkZGluZzogMDttYXJnaW46IDA7d2lkdGg6IDE3NS4wcHg7aGVpZ2h0OiAyMC4wcHg7bGluZS1oZWlnaHQ6IDIwLjBweDtvdmVyZmxvdzogaGlkZGVuO3RleHQtaW5kZW50OiA1LjBweDt3aGl0ZS1zcGFjZTogbm93cmFwOyI+PGEgc3R5bGU9ImNvbG9yOiAjNGU0ZTRlO2ZvbnQtd2VpZ2h0OiBib2xkO3RleHQtZGVjb3JhdGlvbjogbm9uZTsiIHRhcmdldD0iX2JsYW5rIiBocmVmPSJodHRwOi8vaXRlbS50YW9iYW8uY29tL2l0ZW0uaHRtP2lkPTYyMTcwNjQ5NjU1NyI+0JTQtdGC0YHQutC40Lkg0YDQuNGBINC60LDRgNC80LDQvSDQstC+0LTQvtC90LXQv9GA0L7QvdC40YbQsNC10LzRi9C5INGB0LjQu9C40LrQvtC90L7QstGL0Lkg0YHRg9C/0LXRgCDQvNGP0LPQutC40Lkg0YDQvtGCINC00LXRgtGB0LrQvtCz0L4g0YDRgtCwLCDQtNC10YLRgdC60LjQtSDRgNC+0YLRiywg0LTQtdGC0LgsINC10YHRgtGMINC00L7Qv9C+0LvQvdC40YLQtdC70YzQvdCw0Y8g0L/QuNGJ0LAsINCx0LjQsdC40LvQuNGBLCDQutCw0YDQvNCw0L0g0LTQu9GPINC00LXRgtGB0LrQvtC5INC/0LjRidC4INGA0LjRgdCwPC9hPjwvcD48ZGl2IHN0eWxlPSJoZWlnaHQ6IDI1LjBweDttYXJnaW4tdG9wOiA0LjBweDt3aGl0ZS1zcGFjZTogbm93cmFwO3BhZGRpbmc6IDAgNS4wcHg7IiBjbGFzcz0icHJpY2VzIj48cCBzdHlsZT0icGFkZGluZzogMDttYXJnaW46IDA7Y29sb3I6ICNmZTNlNGM7aGVpZ2h0OiAyMC4wcHg7bGluZS1oZWlnaHQ6IDIwLjBweDt0ZXh0LWluZGVudDogNS4wcHg7ZmxvYXQ6IGxlZnQ7Ij48c3BhbiBjbGFzcz0icHJpY2UiPjxzcGFuIGNsYXNzPSJpY29uIj7vv6U8L3NwYW4+PGkgc3R5bGU9ImZvbnQ6IDE4LjBweCBib2xkIHZlcmRhbmEgYXJpYWw7Ij42Ljg8L2k+PC9zcGFuPjwvcD48cCBzdHlsZT0icGFkZGluZzogMDttYXJnaW46IDA7Y29sb3I6ICM5OTk5OTk7Zm9udDogMTIuMHB4IGJvbGQ7bWFyZ2luLWxlZnQ6IDUuMHB4O21hcmdpbi10b3A6IDMuMHB4O2ZvbnQtd2VpZ2h0OiBib2xkO2Zsb2F0OiBsZWZ0OyI+PHNwYW4gc3R5bGU9ImZvbnQtd2VpZ2h0OiBub3JtYWw7dGV4dC1kZWNvcmF0aW9uOiBsaW5lLXRocm91Z2g7IiBjbGFzcz0icHJpY2UiPjxzcGFuIGNsYXNzPSJpY29uIj7vv6U8L3NwYW4+PGk+MTMuNjwvaT48L3NwYW4+PC9wPjwvZGl2PjxkaXYgc3R5bGU9InRleHQtYWxpZ246IGNlbnRlcjt3aWR0aDogMTgwLjBweDsiIGNsYXNzPSJpdGVtLWdvdSI+PHRhYmxlIGNlbGxzcGFjaW5nPSIwIiBjZWxscGFkZGluZz0iMCIgYmFja2dyb3VuZD0iaHR0cHM6Ly9pbWcuYWxpY2RuLmNvbS9pbWdleHRyYS9pMS8yMDg0MTM5OC9UQjJoU21IWFZYWFhYWE1YcFhYWFhYWFhYWFgtMjA4NDEzOTgucG5nIiBzdHlsZT0id2lkdGg6IDEwMC4wJTtiYWNrZ3JvdW5kLXJlcGVhdDogbm8tcmVwZWF0O2JhY2tncm91bmQtcG9zaXRpb246IDUuMHB4IC0zMDAuMHB4OyI+PHRyPjx0ZD48L3RkPjwvdHI+PC90YWJsZT48L2Rpdj48L3RkPjwvdHI+PC90YWJsZT48L3RkPjx0ZCBzdHlsZT0iYm9yZGVyLXJpZ2h0OiAxLjBweCBzb2xpZCAjYzBiZWJmO2JvcmRlci1ib3R0b206IDEuMHB4IHNvbGlkICNjMGJlYmY7d2lkdGg6IDE4Ni4wcHg7cGFkZGluZy1ib3R0b206IDUuMHB4OyI+PHRhYmxlIGNlbGxzcGFjaW5nPSIwIiBjZWxscGFkZGluZz0iMCIgc3R5bGU9IndpZHRoOiAxMDAuMCU7Ym9yZGVyOiAwO2JhY2tncm91bmQtY29sb3I6ICNmZmZmZmY7Ij48dHI+PHRkPjxkaXYgc3R5bGU9ImhlaWdodDogMjUuMHB4O2xpbmUtaGVpZ2h0OiAzMC4wcHg7b3ZlcmZsb3c6IGhpZGRlbjt0ZXh0LWFsaWduOiBjZW50ZXI7d2hpdGUtc3BhY2U6IG5vd3JhcDsiPjxhIHN0eWxlPSJkaXNwbGF5OiBpbmxpbmUtYmxvY2s7Y29sb3I6ICNmZjAwMDA7Zm9udC1zaXplOiAxNC4wcHg7Zm9udC13ZWlnaHQ6IGJvbGQ7cGFkZGluZy1yaWdodDogMTAuMHB4O3RleHQtZGVjb3JhdGlvbjogbm9uZTsiIHRhcmdldD0iX2JsYW5rIiBocmVmPSJodHRwOi8vaXRlbS50YW9iYW8uY29tL2l0ZW0uaHRtP2lkPTYxOTMyMjI4NDQyNyI+0K8g0LTRg9C80LDRjiwg0YLQtdCx0LUg0L/QvtC90YDQsNCy0LjRgtGB0Y88L2E+PC9kaXY+PC90ZD48L3RyPjx0cj48dGQgc3R5bGU9IndpZHRoOiAxODAuMHB4O2hlaWdodDogMTgwLjBweDt0ZXh0LWFsaWduOiBjZW50ZXI7Ij48YSBzdHlsZT0idGV4dC1kZWNvcmF0aW9uOiBub25lO3ZlcnRpY2FsLWFsaWduOiBtaWRkbGU7IiB0YXJnZXQ9Il9ibGFuayIgaHJlZj0iaHR0cDovL2l0ZW0udGFvYmFvLmNvbS9pdGVtLmh0bT9pZD02MTkzMjIyODQ0MjciPjxpbWcgYWx0PSIiIHNyYz0iaHR0cHM6Ly9pbWcuYWxpY2RuLmNvbS9iYW8vdXBsb2FkZWQvaTQvMTM5NjYzOTQ5L08xQ04wMXRvMzcwVzFmMmdmU1BxYW0zXyEhMTM5NjYzOTQ5LmpwZ18xNzB4MTcwLmpwZyI+PC9hPjwvdGQ+PC90cj48dHI+PHRkPjxwIHN0eWxlPSJwYWRkaW5nOiAwO21hcmdpbjogMDt3aWR0aDogMTc1LjBweDtoZWlnaHQ6IDIwLjBweDtsaW5lLWhlaWdodDogMjAuMHB4O292ZXJmbG93OiBoaWRkZW47dGV4dC1pbmRlbnQ6IDUuMHB4O3doaXRlLXNwYWNlOiBub3dyYXA7Ij48YSBzdHlsZT0iY29sb3I6ICM0ZTRlNGU7Zm9udC13ZWlnaHQ6IGJvbGQ7dGV4dC1kZWNvcmF0aW9uOiBub25lOyIgdGFyZ2V0PSJfYmxhbmsiIGhyZWY9Imh0dHA6Ly9pdGVtLnRhb2Jhby5jb20vaXRlbS5odG0/aWQ9NjE5MzIyMjg0NDI3Ij4zMDQg0LjQtyDQvdC10YDQttCw0LLQtdGO0YnQtdC5INGB0YLQsNC70Lgg0LDRgNCx0YPQtyDQu9C+0LbQutCwINC20LXQu9C10LfQvdCw0Y8g0LvQvtC/0LDRgtCwINC00L7QvNCwINC10YjRjCDQtNC10YHQtdGA0YLRiyDQuCDRgdC60YDQuNC/PC9hPjwvcD48ZGl2IHN0eWxlPSJoZWlnaHQ6IDI1LjBweDttYXJnaW4tdG9wOiA0LjBweDt3aGl0ZS1zcGFjZTogbm93cmFwO3BhZGRpbmc6IDAgNS4wcHg7IiBjbGFzcz0icHJpY2VzIj48cCBzdHlsZT0icGFkZGluZzogMDttYXJnaW46IDA7Y29sb3I6ICNmZTNlNGM7aGVpZ2h0OiAyMC4wcHg7bGluZS1oZWlnaHQ6IDIwLjBweDt0ZXh0LWluZGVudDogNS4wcHg7ZmxvYXQ6IGxlZnQ7Ij48c3BhbiBjbGFzcz0icHJpY2UiPjxzcGFuIGNsYXNzPSJpY29uIj7vv6U8L3NwYW4+PGkgc3R5bGU9ImZvbnQ6IDE4LjBweCBib2xkIHZlcmRhbmEgYXJpYWw7Ij40LjY8L2k+PC9zcGFuPjwvcD48cCBzdHlsZT0icGFkZGluZzogMDttYXJnaW46IDA7Y29sb3I6ICM5OTk5OTk7Zm9udDogMTIuMHB4IGJvbGQ7bWFyZ2luLWxlZnQ6IDUuMHB4O21hcmdpbi10b3A6IDMuMHB4O2ZvbnQtd2VpZ2h0OiBib2xkO2Zsb2F0OiBsZWZ0OyI+PHNwYW4gc3R5bGU9ImZvbnQtd2VpZ2h0OiBub3JtYWw7dGV4dC1kZWNvcmF0aW9uOiBsaW5lLXRocm91Z2g7IiBjbGFzcz0icHJpY2UiPjxzcGFuIGNsYXNzPSJpY29uIj7vv6U8L3NwYW4+PGk+NC42PC9pPjwvc3Bhbj48L3A+PC9kaXY+PGRpdiBzdHlsZT0idGV4dC1hbGlnbjogY2VudGVyO3dpZHRoOiAxODAuMHB4OyIgY2xhc3M9Iml0ZW0tZ291Ij48dGFibGUgY2VsbHNwYWNpbmc9IjAiIGNlbGxwYWRkaW5nPSIwIiBiYWNrZ3JvdW5kPSJodHRwczovL2ltZy5hbGljZG4uY29tL2ltZ2V4dHJhL2kxLzIwODQxMzk4L1RCMmhTbUhYVlhYWFhYTVhwWFhYWFhYWFhYWC0yMDg0MTM5OC5wbmciIHN0eWxlPSJ3aWR0aDogMTAwLjAlO2JhY2tncm91bmQtcmVwZWF0OiBuby1yZXBlYXQ7YmFja2dyb3VuZC1wb3NpdGlvbjogNS4wcHggLTMwMC4wcHg7Ij48dHI+PHRkPjwvdGQ+PC90cj48L3RhYmxlPjwvZGl2PjwvdGQ+PC90cj48L3RhYmxlPjwvdGQ+PHRkIHN0eWxlPSJib3JkZXItcmlnaHQ6IDEuMHB4IHNvbGlkICNjMGJlYmY7Ym9yZGVyLWJvdHRvbTogMS4wcHggc29saWQgI2MwYmViZjt3aWR0aDogMTg2LjBweDtwYWRkaW5nLWJvdHRvbTogNS4wcHg7Ij48dGFibGUgY2VsbHNwYWNpbmc9IjAiIGNlbGxwYWRkaW5nPSIwIiBzdHlsZT0id2lkdGg6IDEwMC4wJTtib3JkZXI6IDA7YmFja2dyb3VuZC1jb2xvcjogI2ZmZmZmZjsiPjx0cj48dGQ+PGRpdiBzdHlsZT0iaGVpZ2h0OiAyNS4wcHg7bGluZS1oZWlnaHQ6IDMwLjBweDtvdmVyZmxvdzogaGlkZGVuO3RleHQtYWxpZ246IGNlbnRlcjt3aGl0ZS1zcGFjZTogbm93cmFwOyI+PGEgc3R5bGU9ImRpc3BsYXk6IGlubGluZS1ibG9jaztjb2xvcjogI2ZmMDAwMDtmb250LXNpemU6IDE0LjBweDtmb250LXdlaWdodDogYm9sZDtwYWRkaW5nLXJpZ2h0OiAxMC4wcHg7dGV4dC1kZWNvcmF0aW9uOiBub25lOyIgdGFyZ2V0PSJfYmxhbmsiIGhyZWY9Imh0dHA6Ly9pdGVtLnRhb2Jhby5jb20vaXRlbS5odG0/aWQ9NjE4NzA2NTk4NTA3Ij7QryDQtNGD0LzQsNGOLCDRgtC10LHQtSDQv9C+0L3RgNCw0LLQuNGC0YHRjzwvYT48L2Rpdj48L3RkPjwvdHI+PHRyPjx0ZCBzdHlsZT0id2lkdGg6IDE4MC4wcHg7aGVpZ2h0OiAxODAuMHB4O3RleHQtYWxpZ246IGNlbnRlcjsiPjxhIHN0eWxlPSJ0ZXh0LWRlY29yYXRpb246IG5vbmU7dmVydGljYWwtYWxpZ246IG1pZGRsZTsiIHRhcmdldD0iX2JsYW5rIiBocmVmPSJodHRwOi8vaXRlbS50YW9iYW8uY29tL2l0ZW0uaHRtP2lkPTYxODcwNjU5ODUwNyI+PGltZyBhbHQ9IiIgc3JjPSJodHRwczovL2ltZy5hbGljZG4uY29tL2Jhby91cGxvYWRlZC9pMy8xMzk2NjM5NDkvTzFDTjAxWlJ5YmFCMWYyZ2Fzb0NRMjBfISEwLWl0ZW1fcGljLmpwZ18xNzB4MTcwLmpwZyI+PC9hPjwvdGQ+PC90cj48dHI+PHRkPjxwIHN0eWxlPSJwYWRkaW5nOiAwO21hcmdpbjogMDt3aWR0aDogMTc1LjBweDtoZWlnaHQ6IDIwLjBweDtsaW5lLWhlaWdodDogMjAuMHB4O292ZXJmbG93OiBoaWRkZW47dGV4dC1pbmRlbnQ6IDUuMHB4O3doaXRlLXNwYWNlOiBub3dyYXA7Ij48YSBzdHlsZT0iY29sb3I6ICM0ZTRlNGU7Zm9udC13ZWlnaHQ6IGJvbGQ7dGV4dC1kZWNvcmF0aW9uOiBub25lOyIgdGFyZ2V0PSJfYmxhbmsiIGhyZWY9Imh0dHA6Ly9pdGVtLnRhb2Jhby5jb20vaXRlbS5odG0/aWQ9NjE4NzA2NTk4NTA3Ij7QlNC+0LzQsNGI0L3Rj9GPINGA0YPRh9C90LDRjyDRgNGD0YfQvdCw0Y8g0YHQttC40LzQsNC90LjRjyDRgdC20LjQvNCw0L3QuNGPINGC0YDRjtC60LAg0L3QsCDQutGD0YXQvdGPPC9hPjwvcD48ZGl2IHN0eWxlPSJoZWlnaHQ6IDI1LjBweDttYXJnaW4tdG9wOiA0LjBweDt3aGl0ZS1zcGFjZTogbm93cmFwO3BhZGRpbmc6IDAgNS4wcHg7IiBjbGFzcz0icHJpY2VzIj48cCBzdHlsZT0icGFkZGluZzogMDttYXJnaW46IDA7Y29sb3I6ICNmZTNlNGM7aGVpZ2h0OiAyMC4wcHg7bGluZS1oZWlnaHQ6IDIwLjBweDt0ZXh0LWluZGVudDogNS4wcHg7ZmxvYXQ6IGxlZnQ7Ij48c3BhbiBjbGFzcz0icHJpY2UiPjxzcGFuIGNsYXNzPSJpY29uIj7vv6U8L3NwYW4+PGkgc3R5bGU9ImZvbnQ6IDE4LjBweCBib2xkIHZlcmRhbmEgYXJpYWw7Ij44LjI8L2k+PC9zcGFuPjwvcD48cCBzdHlsZT0icGFkZGluZzogMDttYXJnaW46IDA7Y29sb3I6ICM5OTk5OTk7Zm9udDogMTIuMHB4IGJvbGQ7bWFyZ2luLWxlZnQ6IDUuMHB4O21hcmdpbi10b3A6IDMuMHB4O2ZvbnQtd2VpZ2h0OiBib2xkO2Zsb2F0OiBsZWZ0OyI+PHNwYW4gc3R5bGU9ImZvbnQtd2VpZ2h0OiBub3JtYWw7dGV4dC1kZWNvcmF0aW9uOiBsaW5lLXRocm91Z2g7IiBjbGFzcz0icHJpY2UiPjxzcGFuIGNsYXNzPSJpY29uIj7vv6U8L3NwYW4+PGk+OC4yPC9pPjwvc3Bhbj48L3A+PC9kaXY+PGRpdiBzdHlsZT0idGV4dC1hbGlnbjogY2VudGVyO3dpZHRoOiAxODAuMHB4OyIgY2xhc3M9Iml0ZW0tZ291Ij48dGFibGUgY2VsbHNwYWNpbmc9IjAiIGNlbGxwYWRkaW5nPSIwIiBiYWNrZ3JvdW5kPSJodHRwczovL2ltZy5hbGljZG4uY29tL2ltZ2V4dHJhL2kxLzIwODQxMzk4L1RCMmhTbUhYVlhYWFhYTVhwWFhYWFhYWFhYWC0yMDg0MTM5OC5wbmciIHN0eWxlPSJ3aWR0aDogMTAwLjAlO2JhY2tncm91bmQtcmVwZWF0OiBuby1yZXBlYXQ7YmFja2dyb3VuZC1wb3NpdGlvbjogNS4wcHggLTMwMC4wcHg7Ij48dHI+PHRkPjwvdGQ+PC90cj48L3RhYmxlPjwvZGl2PjwvdGQ+PC90cj48L3RhYmxlPjwvdGQ+PHRkIHN0eWxlPSJib3JkZXItcmlnaHQ6IDEuMHB4IHNvbGlkICNjMGJlYmY7Ym9yZGVyLWJvdHRvbTogMS4wcHggc29saWQgI2MwYmViZjt3aWR0aDogMTg2LjBweDtwYWRkaW5nLWJvdHRvbTogNS4wcHg7Ij48dGFibGUgY2VsbHNwYWNpbmc9IjAiIGNlbGxwYWRkaW5nPSIwIiBzdHlsZT0id2lkdGg6IDEwMC4wJTtib3JkZXI6IDA7YmFja2dyb3VuZC1jb2xvcjogI2ZmZmZmZjsiPjx0cj48dGQ+PGRpdiBzdHlsZT0iaGVpZ2h0OiAyNS4wcHg7bGluZS1oZWlnaHQ6IDMwLjBweDtvdmVyZmxvdzogaGlkZGVuO3RleHQtYWxpZ246IGNlbnRlcjt3aGl0ZS1zcGFjZTogbm93cmFwOyI+PGEgc3R5bGU9ImRpc3BsYXk6IGlubGluZS1ibG9jaztjb2xvcjogI2ZmMDAwMDtmb250LXNpemU6IDE0LjBweDtmb250LXdlaWdodDogYm9sZDtwYWRkaW5nLXJpZ2h0OiAxMC4wcHg7dGV4dC1kZWNvcmF0aW9uOiBub25lOyIgdGFyZ2V0PSJfYmxhbmsiIGhyZWY9Imh0dHA6Ly9pdGVtLnRhb2Jhby5jb20vaXRlbS5odG0/aWQ9NjE4NTAyMzc3NTEzIj7QryDQtNGD0LzQsNGOLCDRgtC10LHQtSDQv9C+0L3RgNCw0LLQuNGC0YHRjzwvYT48L2Rpdj48L3RkPjwvdHI+PHRyPjx0ZCBzdHlsZT0id2lkdGg6IDE4MC4wcHg7aGVpZ2h0OiAxODAuMHB4O3RleHQtYWxpZ246IGNlbnRlcjsiPjxhIHN0eWxlPSJ0ZXh0LWRlY29yYXRpb246IG5vbmU7dmVydGljYWwtYWxpZ246IG1pZGRsZTsiIHRhcmdldD0iX2JsYW5rIiBocmVmPSJodHRwOi8vaXRlbS50YW9iYW8uY29tL2l0ZW0uaHRtP2lkPTYxODUwMjM3NzUxMyI+PGltZyBhbHQ9IiIgc3JjPSJodHRwczovL2ltZy5hbGljZG4uY29tL2Jhby91cGxvYWRlZC9pMS8xMzk2NjM5NDkvTzFDTjAxMWYyZ1dkTlZiWVBjMjY5XyEhMC1pdGVtX3BpYy5qcGdfMTcweDE3MC5qcGciPjwvYT48L3RkPjwvdHI+PHRyPjx0ZD48cCBzdHlsZT0icGFkZGluZzogMDttYXJnaW46IDA7d2lkdGg6IDE3NS4wcHg7aGVpZ2h0OiAyMC4wcHg7bGluZS1oZWlnaHQ6IDIwLjBweDtvdmVyZmxvdzogaGlkZGVuO3RleHQtaW5kZW50OiA1LjBweDt3aGl0ZS1zcGFjZTogbm93cmFwOyI+PGEgc3R5bGU9ImNvbG9yOiAjNGU0ZTRlO2ZvbnQtd2VpZ2h0OiBib2xkO3RleHQtZGVjb3JhdGlvbjogbm9uZTsiIHRhcmdldD0iX2JsYW5rIiBocmVmPSJodHRwOi8vaXRlbS50YW9iYW8uY29tL2l0ZW0uaHRtP2lkPTYxODUwMjM3NzUxMyI+0J/QvtC00LvQuNC90L3Ri9C5INGC0YPQsNC70LXRgtC90YvQuSDQtNC10LfQvtC00L7RgNC40YDRg9GO0YnQuNC5INGB0LjQvdC40Lkg0L/Rg9C30YvRgNGMINC/0YDQvtGH0L3Ri9C5INGC0YPQsNC70LXRgtC90YvQuSDQvtGH0LjRidCw0Y7RidC40Lkg0YLRg9Cw0LvQtdGC0L3Ri9C5INC+0YfQuNGB0YLQuNGC0LXQu9GMINC+0YfQuNGB0YLQuNGC0LXQu9GMPC9hPjwvcD48ZGl2IHN0eWxlPSJoZWlnaHQ6IDI1LjBweDttYXJnaW4tdG9wOiA0LjBweDt3aGl0ZS1zcGFjZTogbm93cmFwO3BhZGRpbmc6IDAgNS4wcHg7IiBjbGFzcz0icHJpY2VzIj48cCBzdHlsZT0icGFkZGluZzogMDttYXJnaW46IDA7Y29sb3I6ICNmZTNlNGM7aGVpZ2h0OiAyMC4wcHg7bGluZS1oZWlnaHQ6IDIwLjBweDt0ZXh0LWluZGVudDogNS4wcHg7ZmxvYXQ6IGxlZnQ7Ij48c3BhbiBjbGFzcz0icHJpY2UiPjxzcGFuIGNsYXNzPSJpY29uIj7vv6U8L3NwYW4+PGkgc3R5bGU9ImZvbnQ6IDE4LjBweCBib2xkIHZlcmRhbmEgYXJpYWw7Ij4xNy4zPC9pPjwvc3Bhbj48L3A+PHAgc3R5bGU9InBhZGRpbmc6IDA7bWFyZ2luOiAwO2NvbG9yOiAjOTk5OTk5O2ZvbnQ6IDEyLjBweCBib2xkO21hcmdpbi1sZWZ0OiA1LjBweDttYXJnaW4tdG9wOiAzLjBweDtmb250LXdlaWdodDogYm9sZDtmbG9hdDogbGVmdDsiPjxzcGFuIHN0eWxlPSJmb250LXdlaWdodDogbm9ybWFsO3RleHQtZGVjb3JhdGlvbjogbGluZS10aHJvdWdoOyIgY2xhc3M9InByaWNlIj48c3BhbiBjbGFzcz0iaWNvbiI+77+lPC9zcGFuPjxpPjE3LjM8L2k+PC9zcGFuPjwvcD48L2Rpdj48ZGl2IHN0eWxlPSJ0ZXh0LWFsaWduOiBjZW50ZXI7d2lkdGg6IDE4MC4wcHg7IiBjbGFzcz0iaXRlbS1nb3UiPjx0YWJsZSBjZWxsc3BhY2luZz0iMCIgY2VsbHBhZGRpbmc9IjAiIGJhY2tncm91bmQ9Imh0dHBzOi8vaW1nLmFsaWNkbi5jb20vaW1nZXh0cmEvaTEvMjA4NDEzOTgvVEIyaFNtSFhWWFhYWFhNWHBYWFhYWFhYWFhYLTIwODQxMzk4LnBuZyIgc3R5bGU9IndpZHRoOiAxMDAuMCU7YmFja2dyb3VuZC1yZXBlYXQ6IG5vLXJlcGVhdDtiYWNrZ3JvdW5kLXBvc2l0aW9uOiA1LjBweCAtMzAwLjBweDsiPjx0cj48dGQ+PC90ZD48L3RyPjwvdGFibGU+PC9kaXY+PC90ZD48L3RyPjwvdGFibGU+PC90ZD48L3RyPjx0cj48dGQgc3R5bGU9ImJvcmRlci1yaWdodDogMS4wcHggc29saWQgI2MwYmViZjtib3JkZXItYm90dG9tOiAxLjBweCBzb2xpZCAjYzBiZWJmO3dpZHRoOiAxODYuMHB4O3BhZGRpbmctYm90dG9tOiA1LjBweDsiPjx0YWJsZSBjZWxsc3BhY2luZz0iMCIgY2VsbHBhZGRpbmc9IjAiIHN0eWxlPSJ3aWR0aDogMTAwLjAlO2JvcmRlcjogMDtiYWNrZ3JvdW5kLWNvbG9yOiAjZmZmZmZmOyI+PHRyPjx0ZD48ZGl2IHN0eWxlPSJoZWlnaHQ6IDI1LjBweDtsaW5lLWhlaWdodDogMzAuMHB4O292ZXJmbG93OiBoaWRkZW47dGV4dC1hbGlnbjogY2VudGVyO3doaXRlLXNwYWNlOiBub3dyYXA7Ij48YSBzdHlsZT0iZGlzcGxheTogaW5saW5lLWJsb2NrO2NvbG9yOiAjZmYwMDAwO2ZvbnQtc2l6ZTogMTQuMHB4O2ZvbnQtd2VpZ2h0OiBib2xkO3BhZGRpbmctcmlnaHQ6IDEwLjBweDt0ZXh0LWRlY29yYXRpb246IG5vbmU7IiB0YXJnZXQ9Il9ibGFuayIgaHJlZj0iaHR0cDovL2l0ZW0udGFvYmFvLmNvbS9pdGVtLmh0bT9pZD02MTg0NjAwODEwNDQiPtCvINC00YPQvNCw0Y4sINGC0LXQsdC1INC/0L7QvdGA0LDQstC40YLRgdGPPC9hPjwvZGl2PjwvdGQ+PC90cj48dHI+PHRkIHN0eWxlPSJ3aWR0aDogMTgwLjBweDtoZWlnaHQ6IDE4MC4wcHg7dGV4dC1hbGlnbjogY2VudGVyOyI+PGEgc3R5bGU9InRleHQtZGVjb3JhdGlvbjogbm9uZTt2ZXJ0aWNhbC1hbGlnbjogbWlkZGxlOyIgdGFyZ2V0PSJfYmxhbmsiIGhyZWY9Imh0dHA6Ly9pdGVtLnRhb2Jhby5jb20vaXRlbS5odG0/aWQ9NjE4NDYwMDgxMDQ0Ij48aW1nIGFsdD0iIiBzcmM9Imh0dHBzOi8vaW1nLmFsaWNkbi5jb20vYmFvL3VwbG9hZGVkL2kyLzEzOTY2Mzk0OS9PMUNOMDExZjJnV3BNODZNN2ZsaEpfISEwLWl0ZW1fcGljLmpwZ18xNzB4MTcwLmpwZyI+PC9hPjwvdGQ+PC90cj48dHI+PHRkPjxwIHN0eWxlPSJwYWRkaW5nOiAwO21hcmdpbjogMDt3aWR0aDogMTc1LjBweDtoZWlnaHQ6IDIwLjBweDtsaW5lLWhlaWdodDogMjAuMHB4O292ZXJmbG93OiBoaWRkZW47dGV4dC1pbmRlbnQ6IDUuMHB4O3doaXRlLXNwYWNlOiBub3dyYXA7Ij48YSBzdHlsZT0iY29sb3I6ICM0ZTRlNGU7Zm9udC13ZWlnaHQ6IGJvbGQ7dGV4dC1kZWNvcmF0aW9uOiBub25lOyIgdGFyZ2V0PSJfYmxhbmsiIGhyZWY9Imh0dHA6Ly9pdGVtLnRhb2Jhby5jb20vaXRlbS5odG0/aWQ9NjE4NDYwMDgxMDQ0Ij7QnNC90L7Qs9C+0L7RhNGD0L3QutGG0LjQvtC90LDQu9GM0L3QsNGPINC+0LHRg9Cy0L3QsNGPINCw0YDRgtC10YTQsNC60YIg0LPRg9Cx0LrQuCDQvNCw0YHQu9CwINGJ0LXRgtC60LAg0YfQtdGA0L3QsNGPINC60L7QttCwPC9hPjwvcD48ZGl2IHN0eWxlPSJoZWlnaHQ6IDI1LjBweDttYXJnaW4tdG9wOiA0LjBweDt3aGl0ZS1zcGFjZTogbm93cmFwO3BhZGRpbmc6IDAgNS4wcHg7IiBjbGFzcz0icHJpY2VzIj48cCBzdHlsZT0icGFkZGluZzogMDttYXJnaW46IDA7Y29sb3I6ICNmZTNlNGM7aGVpZ2h0OiAyMC4wcHg7bGluZS1oZWlnaHQ6IDIwLjBweDt0ZXh0LWluZGVudDogNS4wcHg7ZmxvYXQ6IGxlZnQ7Ij48c3BhbiBjbGFzcz0icHJpY2UiPjxzcGFuIGNsYXNzPSJpY29uIj7vv6U8L3NwYW4+PGkgc3R5bGU9ImZvbnQ6IDE4LjBweCBib2xkIHZlcmRhbmEgYXJpYWw7Ij4xMy41PC9pPjwvc3Bhbj48L3A+PHAgc3R5bGU9InBhZGRpbmc6IDA7bWFyZ2luOiAwO2NvbG9yOiAjOTk5OTk5O2ZvbnQ6IDEyLjBweCBib2xkO21hcmdpbi1sZWZ0OiA1LjBweDttYXJnaW4tdG9wOiAzLjBweDtmb250LXdlaWdodDogYm9sZDtmbG9hdDogbGVmdDsiPjxzcGFuIHN0eWxlPSJmb250LXdlaWdodDogbm9ybWFsO3RleHQtZGVjb3JhdGlvbjogbGluZS10aHJvdWdoOyIgY2xhc3M9InByaWNlIj48c3BhbiBjbGFzcz0iaWNvbiI+77+lPC9zcGFuPjxpPjEzLjU8L2k+PC9zcGFuPjwvcD48L2Rpdj48ZGl2IHN0eWxlPSJ0ZXh0LWFsaWduOiBjZW50ZXI7d2lkdGg6IDE4MC4wcHg7IiBjbGFzcz0iaXRlbS1nb3UiPjx0YWJsZSBjZWxsc3BhY2luZz0iMCIgY2VsbHBhZGRpbmc9IjAiIGJhY2tncm91bmQ9Imh0dHBzOi8vaW1nLmFsaWNkbi5jb20vaW1nZXh0cmEvaTEvMjA4NDEzOTgvVEIyaFNtSFhWWFhYWFhNWHBYWFhYWFhYWFhYLTIwODQxMzk4LnBuZyIgc3R5bGU9IndpZHRoOiAxMDAuMCU7YmFja2dyb3VuZC1yZXBlYXQ6IG5vLXJlcGVhdDtiYWNrZ3JvdW5kLXBvc2l0aW9uOiA1LjBweCAtMzAwLjBweDsiPjx0cj48dGQ+PC90ZD48L3RyPjwvdGFibGU+PC9kaXY+PC90ZD48L3RyPjwvdGFibGU+PC90ZD48dGQgc3R5bGU9ImJvcmRlci1yaWdodDogMS4wcHggc29saWQgI2MwYmViZjtib3JkZXItYm90dG9tOiAxLjBweCBzb2xpZCAjYzBiZWJmO3dpZHRoOiAxODYuMHB4O3BhZGRpbmctYm90dG9tOiA1LjBweDsiPjx0YWJsZSBjZWxsc3BhY2luZz0iMCIgY2VsbHBhZGRpbmc9IjAiIHN0eWxlPSJ3aWR0aDogMTAwLjAlO2JvcmRlcjogMDtiYWNrZ3JvdW5kLWNvbG9yOiAjZmZmZmZmOyI+PHRyPjx0ZD48ZGl2IHN0eWxlPSJoZWlnaHQ6IDI1LjBweDtsaW5lLWhlaWdodDogMzAuMHB4O292ZXJmbG93OiBoaWRkZW47dGV4dC1hbGlnbjogY2VudGVyO3doaXRlLXNwYWNlOiBub3dyYXA7Ij48YSBzdHlsZT0iZGlzcGxheTogaW5saW5lLWJsb2NrO2NvbG9yOiAjZmYwMDAwO2ZvbnQtc2l6ZTogMTQuMHB4O2ZvbnQtd2VpZ2h0OiBib2xkO3BhZGRpbmctcmlnaHQ6IDEwLjBweDt0ZXh0LWRlY29yYXRpb246IG5vbmU7IiB0YXJnZXQ9Il9ibGFuayIgaHJlZj0iaHR0cDovL2l0ZW0udGFvYmFvLmNvbS9pdGVtLmh0bT9pZD02MTgyMDE0NTY4NzUiPtCvINC00YPQvNCw0Y4sINGC0LXQsdC1INC/0L7QvdGA0LDQstC40YLRgdGPPC9hPjwvZGl2PjwvdGQ+PC90cj48dHI+PHRkIHN0eWxlPSJ3aWR0aDogMTgwLjBweDtoZWlnaHQ6IDE4MC4wcHg7dGV4dC1hbGlnbjogY2VudGVyOyI+PGEgc3R5bGU9InRleHQtZGVjb3JhdGlvbjogbm9uZTt2ZXJ0aWNhbC1hbGlnbjogbWlkZGxlOyIgdGFyZ2V0PSJfYmxhbmsiIGhyZWY9Imh0dHA6Ly9pdGVtLnRhb2Jhby5jb20vaXRlbS5odG0/aWQ9NjE4MjAxNDU2ODc1Ij48aW1nIGFsdD0iIiBzcmM9Imh0dHBzOi8vaW1nLmFsaWNkbi5jb20vYmFvL3VwbG9hZGVkL2kxLzEzOTY2Mzk0OS9UQjFMYm9mRll1V0J1TmpTc3pnWFhiOGpWWGFfISEwLWl0ZW1fcGljLmpwZ18xNzB4MTcwLmpwZyI+PC9hPjwvdGQ+PC90cj48dHI+PHRkPjxwIHN0eWxlPSJwYWRkaW5nOiAwO21hcmdpbjogMDt3aWR0aDogMTc1LjBweDtoZWlnaHQ6IDIwLjBweDtsaW5lLWhlaWdodDogMjAuMHB4O292ZXJmbG93OiBoaWRkZW47dGV4dC1pbmRlbnQ6IDUuMHB4O3doaXRlLXNwYWNlOiBub3dyYXA7Ij48YSBzdHlsZT0iY29sb3I6ICM0ZTRlNGU7Zm9udC13ZWlnaHQ6IGJvbGQ7dGV4dC1kZWNvcmF0aW9uOiBub25lOyIgdGFyZ2V0PSJfYmxhbmsiIGhyZWY9Imh0dHA6Ly9pdGVtLnRhb2Jhby5jb20vaXRlbS5odG0/aWQ9NjE4MjAxNDU2ODc1Ij7QmtGD0YXQvtC90L3QsNGPINCy0L7QtNCwINCR0L7Qu9GM0YjQvtC5INC60LDRgNGC0L7Rh9C60LAg0LPQu9C40L/QvyDQo9GB0YLQsNC90L7QstC40YLQtSDQstCw0L3QvdGD0Y4g0LrQvtC80L3QsNGC0YMg0LTQu9GPINCy0LDQvdC90L7QuSDQv9GA0YPQtCAt0YXRgNCw0L3QtdC90LjQtSDQtNC+0LzQsCDQtNGA0LDQutC+0L08L2E+PC9wPjxkaXYgc3R5bGU9ImhlaWdodDogMjUuMHB4O21hcmdpbi10b3A6IDQuMHB4O3doaXRlLXNwYWNlOiBub3dyYXA7cGFkZGluZzogMCA1LjBweDsiIGNsYXNzPSJwcmljZXMiPjxwIHN0eWxlPSJwYWRkaW5nOiAwO21hcmdpbjogMDtjb2xvcjogI2ZlM2U0YztoZWlnaHQ6IDIwLjBweDtsaW5lLWhlaWdodDogMjAuMHB4O3RleHQtaW5kZW50OiA1LjBweDtmbG9hdDogbGVmdDsiPjxzcGFuIGNsYXNzPSJwcmljZSI+PHNwYW4gY2xhc3M9Imljb24iPu+/pTwvc3Bhbj48aSBzdHlsZT0iZm9udDogMTguMHB4IGJvbGQgdmVyZGFuYSBhcmlhbDsiPjg8L2k+PC9zcGFuPjwvcD48cCBzdHlsZT0icGFkZGluZzogMDttYXJnaW46IDA7Y29sb3I6ICM5OTk5OTk7Zm9udDogMTIuMHB4IGJvbGQ7bWFyZ2luLWxlZnQ6IDUuMHB4O21hcmdpbi10b3A6IDMuMHB4O2ZvbnQtd2VpZ2h0OiBib2xkO2Zsb2F0OiBsZWZ0OyI+PHNwYW4gc3R5bGU9ImZvbnQtd2VpZ2h0OiBub3JtYWw7dGV4dC1kZWNvcmF0aW9uOiBsaW5lLXRocm91Z2g7IiBjbGFzcz0icHJpY2UiPjxzcGFuIGNsYXNzPSJpY29uIj7vv6U8L3NwYW4+PGk+ODwvaT48L3NwYW4+PC9wPjwvZGl2PjxkaXYgc3R5bGU9InRleHQtYWxpZ246IGNlbnRlcjt3aWR0aDogMTgwLjBweDsiIGNsYXNzPSJpdGVtLWdvdSI+PHRhYmxlIGNlbGxzcGFjaW5nPSIwIiBjZWxscGFkZGluZz0iMCIgYmFja2dyb3VuZD0iaHR0cHM6Ly9pbWcuYWxpY2RuLmNvbS9pbWdleHRyYS9pMS8yMDg0MTM5OC9UQjJoU21IWFZYWFhYWE1YcFhYWFhYWFhYWFgtMjA4NDEzOTgucG5nIiBzdHlsZT0id2lkdGg6IDEwMC4wJTtiYWNrZ3JvdW5kLXJlcGVhdDogbm8tcmVwZWF0O2JhY2tncm91bmQtcG9zaXRpb246IDUuMHB4IC0zMDAuMHB4OyI+PHRyPjx0ZD48L3RkPjwvdHI+PC90YWJsZT48L2Rpdj48L3RkPjwvdHI+PC90YWJsZT48L3RkPjx0ZCBzdHlsZT0iYm9yZGVyLXJpZ2h0OiAxLjBweCBzb2xpZCAjYzBiZWJmO2JvcmRlci1ib3R0b206IDEuMHB4IHNvbGlkICNjMGJlYmY7d2lkdGg6IDE4Ni4wcHg7cGFkZGluZy1ib3R0b206IDUuMHB4OyI+PHRhYmxlIGNlbGxzcGFjaW5nPSIwIiBjZWxscGFkZGluZz0iMCIgc3R5bGU9IndpZHRoOiAxMDAuMCU7Ym9yZGVyOiAwO2JhY2tncm91bmQtY29sb3I6ICNmZmZmZmY7Ij48dHI+PHRkPjxkaXYgc3R5bGU9ImhlaWdodDogMjUuMHB4O2xpbmUtaGVpZ2h0OiAzMC4wcHg7b3ZlcmZsb3c6IGhpZGRlbjt0ZXh0LWFsaWduOiBjZW50ZXI7d2hpdGUtc3BhY2U6IG5vd3JhcDsiPjxhIHN0eWxlPSJkaXNwbGF5OiBpbmxpbmUtYmxvY2s7Y29sb3I6ICNmZjAwMDA7Zm9udC1zaXplOiAxNC4wcHg7Zm9udC13ZWlnaHQ6IGJvbGQ7cGFkZGluZy1yaWdodDogMTAuMHB4O3RleHQtZGVjb3JhdGlvbjogbm9uZTsiIHRhcmdldD0iX2JsYW5rIiBocmVmPSJodHRwOi8vaXRlbS50YW9iYW8uY29tL2l0ZW0uaHRtP2lkPTYxODE5MzE3NjU1MiI+0K8g0LTRg9C80LDRjiwg0YLQtdCx0LUg0L/QvtC90YDQsNCy0LjRgtGB0Y88L2E+PC9kaXY+PC90ZD48L3RyPjx0cj48dGQgc3R5bGU9IndpZHRoOiAxODAuMHB4O2hlaWdodDogMTgwLjBweDt0ZXh0LWFsaWduOiBjZW50ZXI7Ij48YSBzdHlsZT0idGV4dC1kZWNvcmF0aW9uOiBub25lO3ZlcnRpY2FsLWFsaWduOiBtaWRkbGU7IiB0YXJnZXQ9Il9ibGFuayIgaHJlZj0iaHR0cDovL2l0ZW0udGFvYmFvLmNvbS9pdGVtLmh0bT9pZD02MTgxOTMxNzY1NTIiPjxpbWcgYWx0PSIiIHNyYz0iaHR0cHM6Ly9pbWcuYWxpY2RuLmNvbS9iYW8vdXBsb2FkZWQvaTIvMTM5NjYzOTQ5L08xQ04wMVNOQXVkbTFmMmdmRTJYZTVtXyEhMTM5NjYzOTQ5LmpwZ18xNzB4MTcwLmpwZyI+PC9hPjwvdGQ+PC90cj48dHI+PHRkPjxwIHN0eWxlPSJwYWRkaW5nOiAwO21hcmdpbjogMDt3aWR0aDogMTc1LjBweDtoZWlnaHQ6IDIwLjBweDtsaW5lLWhlaWdodDogMjAuMHB4O292ZXJmbG93OiBoaWRkZW47dGV4dC1pbmRlbnQ6IDUuMHB4O3doaXRlLXNwYWNlOiBub3dyYXA7Ij48YSBzdHlsZT0iY29sb3I6ICM0ZTRlNGU7Zm9udC13ZWlnaHQ6IGJvbGQ7dGV4dC1kZWNvcmF0aW9uOiBub25lOyIgdGFyZ2V0PSJfYmxhbmsiIGhyZWY9Imh0dHA6Ly9pdGVtLnRhb2Jhby5jb20vaXRlbS5odG0/aWQ9NjE4MTkzMTc2NTUyIj7QrtC20L3QvtC60L7RgNC10LnRgdC60LDRjyDRiNCw0LzQv9GD0L3RjCDQtNC70Y8g0LLQvtC30LTRg9GI0L3QvtC5INC/0L7QtNGD0YjQutC4INCT0YDQsNCx0YfQsNGC0LDRjyDQs9C+0LvQvtCy0LrQsCDQvNC10YDQuNC00LjQsNC90YHQutCw0Y8g0YDQsNGB0YfQtdGB0LrQsCwg0LrQvtC20LAsINC80LDRgdGB0LDQttC90L7QtSDRg9GB0YLRgNC+0LnRgdGC0LLQviDQv9GA0L7RgtC40LIg0YjQsNC80L/Rg9C90Y8g0LTQu9GPINGI0LDQvNC/0YPQvdGPPC9hPjwvcD48ZGl2IHN0eWxlPSJoZWlnaHQ6IDI1LjBweDttYXJnaW4tdG9wOiA0LjBweDt3aGl0ZS1zcGFjZTogbm93cmFwO3BhZGRpbmc6IDAgNS4wcHg7IiBjbGFzcz0icHJpY2VzIj48cCBzdHlsZT0icGFkZGluZzogMDttYXJnaW46IDA7Y29sb3I6ICNmZTNlNGM7aGVpZ2h0OiAyMC4wcHg7bGluZS1oZWlnaHQ6IDIwLjBweDt0ZXh0LWluZGVudDogNS4wcHg7ZmxvYXQ6IGxlZnQ7Ij48c3BhbiBjbGFzcz0icHJpY2UiPjxzcGFuIGNsYXNzPSJpY29uIj7vv6U8L3NwYW4+PGkgc3R5bGU9ImZvbnQ6IDE4LjBweCBib2xkIHZlcmRhbmEgYXJpYWw7Ij42LjI8L2k+PC9zcGFuPjwvcD48cCBzdHlsZT0icGFkZGluZzogMDttYXJnaW46IDA7Y29sb3I6ICM5OTk5OTk7Zm9udDogMTIuMHB4IGJvbGQ7bWFyZ2luLWxlZnQ6IDUuMHB4O21hcmdpbi10b3A6IDMuMHB4O2ZvbnQtd2VpZ2h0OiBib2xkO2Zsb2F0OiBsZWZ0OyI+PHNwYW4gc3R5bGU9ImZvbnQtd2VpZ2h0OiBub3JtYWw7dGV4dC1kZWNvcmF0aW9uOiBsaW5lLXRocm91Z2g7IiBjbGFzcz0icHJpY2UiPjxzcGFuIGNsYXNzPSJpY29uIj7vv6U8L3NwYW4+PGk+Ni4yPC9pPjwvc3Bhbj48L3A+PC9kaXY+PGRpdiBzdHlsZT0idGV4dC1hbGlnbjogY2VudGVyO3dpZHRoOiAxODAuMHB4OyIgY2xhc3M9Iml0ZW0tZ291Ij48dGFibGUgY2VsbHNwYWNpbmc9IjAiIGNlbGxwYWRkaW5nPSIwIiBiYWNrZ3JvdW5kPSJodHRwczovL2ltZy5hbGljZG4uY29tL2ltZ2V4dHJhL2kxLzIwODQxMzk4L1RCMmhTbUhYVlhYWFhYTVhwWFhYWFhYWFhYWC0yMDg0MTM5OC5wbmciIHN0eWxlPSJ3aWR0aDogMTAwLjAlO2JhY2tncm91bmQtcmVwZWF0OiBuby1yZXBlYXQ7YmFja2dyb3VuZC1wb3NpdGlvbjogNS4wcHggLTMwMC4wcHg7Ij48dHI+PHRkPjwvdGQ+PC90cj48L3RhYmxlPjwvZGl2PjwvdGQ+PC90cj48L3RhYmxlPjwvdGQ+PHRkIHN0eWxlPSJib3JkZXItcmlnaHQ6IDEuMHB4IHNvbGlkICNjMGJlYmY7Ym9yZGVyLWJvdHRvbTogMS4wcHggc29saWQgI2MwYmViZjt3aWR0aDogMTg2LjBweDtwYWRkaW5nLWJvdHRvbTogNS4wcHg7Ij48dGFibGUgY2VsbHNwYWNpbmc9IjAiIGNlbGxwYWRkaW5nPSIwIiBzdHlsZT0id2lkdGg6IDEwMC4wJTtib3JkZXI6IDA7YmFja2dyb3VuZC1jb2xvcjogI2ZmZmZmZjsiPjx0cj48dGQ+PGRpdiBzdHlsZT0iaGVpZ2h0OiAyNS4wcHg7bGluZS1oZWlnaHQ6IDMwLjBweDtvdmVyZmxvdzogaGlkZGVuO3RleHQtYWxpZ246IGNlbnRlcjt3aGl0ZS1zcGFjZTogbm93cmFwOyI+PGEgc3R5bGU9ImRpc3BsYXk6IGlubGluZS1ibG9jaztjb2xvcjogI2ZmMDAwMDtmb250LXNpemU6IDE0LjBweDtmb250LXdlaWdodDogYm9sZDtwYWRkaW5nLXJpZ2h0OiAxMC4wcHg7dGV4dC1kZWNvcmF0aW9uOiBub25lOyIgdGFyZ2V0PSJfYmxhbmsiIGhyZWY9Imh0dHA6Ly9pdGVtLnRhb2Jhby5jb20vaXRlbS5odG0/aWQ9NjEzMjE3MDc0OTkzIj7QryDQtNGD0LzQsNGOLCDRgtC10LHQtSDQv9C+0L3RgNCw0LLQuNGC0YHRjzwvYT48L2Rpdj48L3RkPjwvdHI+PHRyPjx0ZCBzdHlsZT0id2lkdGg6IDE4MC4wcHg7aGVpZ2h0OiAxODAuMHB4O3RleHQtYWxpZ246IGNlbnRlcjsiPjxhIHN0eWxlPSJ0ZXh0LWRlY29yYXRpb246IG5vbmU7dmVydGljYWwtYWxpZ246IG1pZGRsZTsiIHRhcmdldD0iX2JsYW5rIiBocmVmPSJodHRwOi8vaXRlbS50YW9iYW8uY29tL2l0ZW0uaHRtP2lkPTYxMzIxNzA3NDk5MyI+PGltZyBhbHQ9IiIgc3JjPSJodHRwczovL2ltZy5hbGljZG4uY29tL2Jhby91cGxvYWRlZC9pMi8xMzk2NjM5NDkvTzFDTjAxMHR6dlpoMWYyZ2VMMzZqNHhfISEwLWl0ZW1fcGljLmpwZ18xNzB4MTcwLmpwZyI+PC9hPjwvdGQ+PC90cj48dHI+PHRkPjxwIHN0eWxlPSJwYWRkaW5nOiAwO21hcmdpbjogMDt3aWR0aDogMTc1LjBweDtoZWlnaHQ6IDIwLjBweDtsaW5lLWhlaWdodDogMjAuMHB4O292ZXJmbG93OiBoaWRkZW47dGV4dC1pbmRlbnQ6IDUuMHB4O3doaXRlLXNwYWNlOiBub3dyYXA7Ij48YSBzdHlsZT0iY29sb3I6ICM0ZTRlNGU7Zm9udC13ZWlnaHQ6IGJvbGQ7dGV4dC1kZWNvcmF0aW9uOiBub25lOyIgdGFyZ2V0PSJfYmxhbmsiIGhyZWY9Imh0dHA6Ly9pdGVtLnRhb2Jhby5jb20vaXRlbS5odG0/aWQ9NjEzMjE3MDc0OTkzIj7QodGC0LXQvdCwIC3QodCy0Y/Qt9Cw0L3QvdCw0Y8g0LLQtdGA0YLQuNC60LDQu9GM0L3QsNGPINGD0L3QuNCy0LXRgNGB0LDQu9GM0L3QsNGPINCy0L7Qt9C00YPRiNC90LDRjyDQutC+0L3QtNC40YbQuNC+0L3QtdGAPC9hPjwvcD48ZGl2IHN0eWxlPSJoZWlnaHQ6IDI1LjBweDttYXJnaW4tdG9wOiA0LjBweDt3aGl0ZS1zcGFjZTogbm93cmFwO3BhZGRpbmc6IDAgNS4wcHg7IiBjbGFzcz0icHJpY2VzIj48cCBzdHlsZT0icGFkZGluZzogMDttYXJnaW46IDA7Y29sb3I6ICNmZTNlNGM7aGVpZ2h0OiAyMC4wcHg7bGluZS1oZWlnaHQ6IDIwLjBweDt0ZXh0LWluZGVudDogNS4wcHg7ZmxvYXQ6IGxlZnQ7Ij48c3BhbiBjbGFzcz0icHJpY2UiPjxzcGFuIGNsYXNzPSJpY29uIj7vv6U8L3NwYW4+PGkgc3R5bGU9ImZvbnQ6IDE4LjBweCBib2xkIHZlcmRhbmEgYXJpYWw7Ij4xMS44PC9pPjwvc3Bhbj48L3A+PHAgc3R5bGU9InBhZGRpbmc6IDA7bWFyZ2luOiAwO2NvbG9yOiAjOTk5OTk5O2ZvbnQ6IDEyLjBweCBib2xkO21hcmdpbi1sZWZ0OiA1LjBweDttYXJnaW4tdG9wOiAzLjBweDtmb250LXdlaWdodDogYm9sZDtmbG9hdDogbGVmdDsiPjxzcGFuIHN0eWxlPSJmb250LXdlaWdodDogbm9ybWFsO3RleHQtZGVjb3JhdGlvbjogbGluZS10aHJvdWdoOyIgY2xhc3M9InByaWNlIj48c3BhbiBjbGFzcz0iaWNvbiI+77+lPC9zcGFuPjxpPjIzLjY8L2k+PC9zcGFuPjwvcD48L2Rpdj48ZGl2IHN0eWxlPSJ0ZXh0LWFsaWduOiBjZW50ZXI7d2lkdGg6IDE4MC4wcHg7IiBjbGFzcz0iaXRlbS1nb3UiPjx0YWJsZSBjZWxsc3BhY2luZz0iMCIgY2VsbHBhZGRpbmc9IjAiIGJhY2tncm91bmQ9Imh0dHBzOi8vaW1nLmFsaWNkbi5jb20vaW1nZXh0cmEvaTEvMjA4NDEzOTgvVEIyaFNtSFhWWFhYWFhNWHBYWFhYWFhYWFhYLTIwODQxMzk4LnBuZyIgc3R5bGU9IndpZHRoOiAxMDAuMCU7YmFja2dyb3VuZC1yZXBlYXQ6IG5vLXJlcGVhdDtiYWNrZ3JvdW5kLXBvc2l0aW9uOiA1LjBweCAtMzAwLjBweDsiPjx0cj48dGQ+PC90ZD48L3RyPjwvdGFibGU+PC9kaXY+PC90ZD48L3RyPjwvdGFibGU+PC90ZD48L3RyPjx0cj48dGQgc3R5bGU9ImJvcmRlci1yaWdodDogMS4wcHggc29saWQgI2MwYmViZjtib3JkZXItYm90dG9tOiAxLjBweCBzb2xpZCAjYzBiZWJmO3dpZHRoOiAxODYuMHB4O3BhZGRpbmctYm90dG9tOiA1LjBweDsiPjx0YWJsZSBjZWxsc3BhY2luZz0iMCIgY2VsbHBhZGRpbmc9IjAiIHN0eWxlPSJ3aWR0aDogMTAwLjAlO2JvcmRlcjogMDtiYWNrZ3JvdW5kLWNvbG9yOiAjZmZmZmZmOyI+PHRyPjx0ZD48ZGl2IHN0eWxlPSJoZWlnaHQ6IDI1LjBweDtsaW5lLWhlaWdodDogMzAuMHB4O292ZXJmbG93OiBoaWRkZW47dGV4dC1hbGlnbjogY2VudGVyO3doaXRlLXNwYWNlOiBub3dyYXA7Ij48YSBzdHlsZT0iZGlzcGxheTogaW5saW5lLWJsb2NrO2NvbG9yOiAjZmYwMDAwO2ZvbnQtc2l6ZTogMTQuMHB4O2ZvbnQtd2VpZ2h0OiBib2xkO3BhZGRpbmctcmlnaHQ6IDEwLjBweDt0ZXh0LWRlY29yYXRpb246IG5vbmU7IiB0YXJnZXQ9Il9ibGFuayIgaHJlZj0iaHR0cDovL2l0ZW0udGFvYmFvLmNvbS9pdGVtLmh0bT9pZD01ODkwMTg4NTQ5NzYiPtCvINC00YPQvNCw0Y4sINGC0LXQsdC1INC/0L7QvdGA0LDQstC40YLRgdGPPC9hPjwvZGl2PjwvdGQ+PC90cj48dHI+PHRkIHN0eWxlPSJ3aWR0aDogMTgwLjBweDtoZWlnaHQ6IDE4MC4wcHg7dGV4dC1hbGlnbjogY2VudGVyOyI+PGEgc3R5bGU9InRleHQtZGVjb3JhdGlvbjogbm9uZTt2ZXJ0aWNhbC1hbGlnbjogbWlkZGxlOyIgdGFyZ2V0PSJfYmxhbmsiIGhyZWY9Imh0dHA6Ly9pdGVtLnRhb2Jhby5jb20vaXRlbS5odG0/aWQ9NTg5MDE4ODU0OTc2Ij48aW1nIGFsdD0iIiBzcmM9Imh0dHBzOi8vaW1nLmFsaWNkbi5jb20vYmFvL3VwbG9hZGVkL2kzLzEzOTY2Mzk0OS9PMUNOMDFTdGJZNnQxZjJnWmg2bk1TNl8hITAtaXRlbV9waWMuanBnXzE3MHgxNzAuanBnIj48L2E+PC90ZD48L3RyPjx0cj48dGQ+PHAgc3R5bGU9InBhZGRpbmc6IDA7bWFyZ2luOiAwO3dpZHRoOiAxNzUuMHB4O2hlaWdodDogMjAuMHB4O2xpbmUtaGVpZ2h0OiAyMC4wcHg7b3ZlcmZsb3c6IGhpZGRlbjt0ZXh0LWluZGVudDogNS4wcHg7d2hpdGUtc3BhY2U6IG5vd3JhcDsiPjxhIHN0eWxlPSJjb2xvcjogIzRlNGU0ZTtmb250LXdlaWdodDogYm9sZDt0ZXh0LWRlY29yYXRpb246IG5vbmU7IiB0YXJnZXQ9Il9ibGFuayIgaHJlZj0iaHR0cDovL2l0ZW0udGFvYmFvLmNvbS9pdGVtLmh0bT9pZD01ODkwMTg4NTQ5NzYiPtCd0LDQvdC+IC3QsdC10LfQt9Cw0LzQsNGI0L3QsNGPINC80LDQs9C40YfQtdGB0LrQsNGPINC90LDQutC70LXQudC60LAsINC80L7RidC90LDRjyDQu9C40L/QutCw0Y8sINGE0LjQutGB0LjRgNC+0LLQsNC90L3QsNGPINGB0YLQtdC90LAsINC00LLQvtC50L3QsNGPINGA0LXQt9C40L3QvtCy0LDRjyDQstCw0L3QvdCw0Y8g0LrQvtC80L3QsNGC0LAg0LLQvtC00L7QvdC10L/RgNC+0L3QuNGG0LDQtdC80LDRjyDQv9GA0L7Qt9GA0LDRh9C90LDRjyDQtNCy0L7QudC90LDRjyDQvdCw0LrQu9C10LnQutCwPC9hPjwvcD48ZGl2IHN0eWxlPSJoZWlnaHQ6IDI1LjBweDttYXJnaW4tdG9wOiA0LjBweDt3aGl0ZS1zcGFjZTogbm93cmFwO3BhZGRpbmc6IDAgNS4wcHg7IiBjbGFzcz0icHJpY2VzIj48cCBzdHlsZT0icGFkZGluZzogMDttYXJnaW46IDA7Y29sb3I6ICNmZTNlNGM7aGVpZ2h0OiAyMC4wcHg7bGluZS1oZWlnaHQ6IDIwLjBweDt0ZXh0LWluZGVudDogNS4wcHg7ZmxvYXQ6IGxlZnQ7Ij48c3BhbiBjbGFzcz0icHJpY2UiPjxzcGFuIGNsYXNzPSJpY29uIj7vv6U8L3NwYW4+PGkgc3R5bGU9ImZvbnQ6IDE4LjBweCBib2xkIHZlcmRhbmEgYXJpYWw7Ij44LjI8L2k+PC9zcGFuPjwvcD48cCBzdHlsZT0icGFkZGluZzogMDttYXJnaW46IDA7Y29sb3I6ICM5OTk5OTk7Zm9udDogMTIuMHB4IGJvbGQ7bWFyZ2luLWxlZnQ6IDUuMHB4O21hcmdpbi10b3A6IDMuMHB4O2ZvbnQtd2VpZ2h0OiBib2xkO2Zsb2F0OiBsZWZ0OyI+PHNwYW4gc3R5bGU9ImZvbnQtd2VpZ2h0OiBub3JtYWw7dGV4dC1kZWNvcmF0aW9uOiBsaW5lLXRocm91Z2g7IiBjbGFzcz0icHJpY2UiPjxzcGFuIGNsYXNzPSJpY29uIj7vv6U8L3NwYW4+PGk+MTYuNDwvaT48L3NwYW4+PC9wPjwvZGl2PjxkaXYgc3R5bGU9InRleHQtYWxpZ246IGNlbnRlcjt3aWR0aDogMTgwLjBweDsiIGNsYXNzPSJpdGVtLWdvdSI+PHRhYmxlIGNlbGxzcGFjaW5nPSIwIiBjZWxscGFkZGluZz0iMCIgYmFja2dyb3VuZD0iaHR0cHM6Ly9pbWcuYWxpY2RuLmNvbS9pbWdleHRyYS9pMS8yMDg0MTM5OC9UQjJoU21IWFZYWFhYWE1YcFhYWFhYWFhYWFgtMjA4NDEzOTgucG5nIiBzdHlsZT0id2lkdGg6IDEwMC4wJTtiYWNrZ3JvdW5kLXJlcGVhdDogbm8tcmVwZWF0O2JhY2tncm91bmQtcG9zaXRpb246IDUuMHB4IC0zMDAuMHB4OyI+PHRyPjx0ZD48L3RkPjwvdHI+PC90YWJsZT48L2Rpdj48L3RkPjwvdHI+PC90YWJsZT48L3RkPjx0ZCBzdHlsZT0iYm9yZGVyLXJpZ2h0OiAxLjBweCBzb2xpZCAjYzBiZWJmO2JvcmRlci1ib3R0b206IDEuMHB4IHNvbGlkICNjMGJlYmY7d2lkdGg6IDE4Ni4wcHg7cGFkZGluZy1ib3R0b206IDUuMHB4OyI+PHRhYmxlIGNlbGxzcGFjaW5nPSIwIiBjZWxscGFkZGluZz0iMCIgc3R5bGU9IndpZHRoOiAxMDAuMCU7Ym9yZGVyOiAwO2JhY2tncm91bmQtY29sb3I6ICNmZmZmZmY7Ij48dHI+PHRkPjxkaXYgc3R5bGU9ImhlaWdodDogMjUuMHB4O2xpbmUtaGVpZ2h0OiAzMC4wcHg7b3ZlcmZsb3c6IGhpZGRlbjt0ZXh0LWFsaWduOiBjZW50ZXI7d2hpdGUtc3BhY2U6IG5vd3JhcDsiPjxhIHN0eWxlPSJkaXNwbGF5OiBpbmxpbmUtYmxvY2s7Y29sb3I6ICNmZjAwMDA7Zm9udC1zaXplOiAxNC4wcHg7Zm9udC13ZWlnaHQ6IGJvbGQ7cGFkZGluZy1yaWdodDogMTAuMHB4O3RleHQtZGVjb3JhdGlvbjogbm9uZTsiIHRhcmdldD0iX2JsYW5rIiBocmVmPSJodHRwOi8vaXRlbS50YW9iYW8uY29tL2l0ZW0uaHRtP2lkPTU3MjEwMTUxMDA1MSI+0K8g0LTRg9C80LDRjiwg0YLQtdCx0LUg0L/QvtC90YDQsNCy0LjRgtGB0Y88L2E+PC9kaXY+PC90ZD48L3RyPjx0cj48dGQgc3R5bGU9IndpZHRoOiAxODAuMHB4O2hlaWdodDogMTgwLjBweDt0ZXh0LWFsaWduOiBjZW50ZXI7Ij48YSBzdHlsZT0idGV4dC1kZWNvcmF0aW9uOiBub25lO3ZlcnRpY2FsLWFsaWduOiBtaWRkbGU7IiB0YXJnZXQ9Il9ibGFuayIgaHJlZj0iaHR0cDovL2l0ZW0udGFvYmFvLmNvbS9pdGVtLmh0bT9pZD01NzIxMDE1MTAwNTEiPjxpbWcgYWx0PSIiIHNyYz0iaHR0cHM6Ly9pbWcuYWxpY2RuLmNvbS9iYW8vdXBsb2FkZWQvaTQvMTM5NjYzOTQ5L1RCMVdtUXRpWXNyQktOalNaRnBYWGNYaEZYYV8hITAtaXRlbV9waWMuanBnXzE3MHgxNzAuanBnIj48L2E+PC90ZD48L3RyPjx0cj48dGQ+PHAgc3R5bGU9InBhZGRpbmc6IDA7bWFyZ2luOiAwO3dpZHRoOiAxNzUuMHB4O2hlaWdodDogMjAuMHB4O2xpbmUtaGVpZ2h0OiAyMC4wcHg7b3ZlcmZsb3c6IGhpZGRlbjt0ZXh0LWluZGVudDogNS4wcHg7d2hpdGUtc3BhY2U6IG5vd3JhcDsiPjxhIHN0eWxlPSJjb2xvcjogIzRlNGU0ZTtmb250LXdlaWdodDogYm9sZDt0ZXh0LWRlY29yYXRpb246IG5vbmU7IiB0YXJnZXQ9Il9ibGFuayIgaHJlZj0iaHR0cDovL2l0ZW0udGFvYmFvLmNvbS9pdGVtLmh0bT9pZD01NzIxMDE1MTAwNTEiPtCc0L3QvtCz0L7RhNGD0L3QutGG0LjQvtC90LDQu9GM0L3QsNGPINC90LDRgdGC0LXQvdC90LDRjyDQvdCw0YHRgtC10L3QvdCw0Y8g0L3QsNGB0YLQtdC90L3QsNGPINC30LDQttCw0LLQutCwINC80L7RidC90L48L2E+PC9wPjxkaXYgc3R5bGU9ImhlaWdodDogMjUuMHB4O21hcmdpbi10b3A6IDQuMHB4O3doaXRlLXNwYWNlOiBub3dyYXA7cGFkZGluZzogMCA1LjBweDsiIGNsYXNzPSJwcmljZXMiPjxwIHN0eWxlPSJwYWRkaW5nOiAwO21hcmdpbjogMDtjb2xvcjogI2ZlM2U0YztoZWlnaHQ6IDIwLjBweDtsaW5lLWhlaWdodDogMjAuMHB4O3RleHQtaW5kZW50OiA1LjBweDtmbG9hdDogbGVmdDsiPjxzcGFuIGNsYXNzPSJwcmljZSI+PHNwYW4gY2xhc3M9Imljb24iPu+/pTwvc3Bhbj48aSBzdHlsZT0iZm9udDogMTguMHB4IGJvbGQgdmVyZGFuYSBhcmlhbDsiPjYuMzwvaT48L3NwYW4+PC9wPjxwIHN0eWxlPSJwYWRkaW5nOiAwO21hcmdpbjogMDtjb2xvcjogIzk5OTk5OTtmb250OiAxMi4wcHggYm9sZDttYXJnaW4tbGVmdDogNS4wcHg7bWFyZ2luLXRvcDogMy4wcHg7Zm9udC13ZWlnaHQ6IGJvbGQ7ZmxvYXQ6IGxlZnQ7Ij48c3BhbiBzdHlsZT0iZm9udC13ZWlnaHQ6IG5vcm1hbDt0ZXh0LWRlY29yYXRpb246IGxpbmUtdGhyb3VnaDsiIGNsYXNzPSJwcmljZSI+PHNwYW4gY2xhc3M9Imljb24iPu+/pTwvc3Bhbj48aT4xMi42PC9pPjwvc3Bhbj48L3A+PC9kaXY+PGRpdiBzdHlsZT0idGV4dC1hbGlnbjogY2VudGVyO3dpZHRoOiAxODAuMHB4OyIgY2xhc3M9Iml0ZW0tZ291Ij48dGFibGUgY2VsbHNwYWNpbmc9IjAiIGNlbGxwYWRkaW5nPSIwIiBiYWNrZ3JvdW5kPSJodHRwczovL2ltZy5hbGljZG4uY29tL2ltZ2V4dHJhL2kxLzIwODQxMzk4L1RCMmhTbUhYVlhYWFhYTVhwWFhYWFhYWFhYWC0yMDg0MTM5OC5wbmciIHN0eWxlPSJ3aWR0aDogMTAwLjAlO2JhY2tncm91bmQtcmVwZWF0OiBuby1yZXBlYXQ7YmFja2dyb3VuZC1wb3NpdGlvbjogNS4wcHggLTMwMC4wcHg7Ij48dHI+PHRkPjwvdGQ+PC90cj48L3RhYmxlPjwvZGl2PjwvdGQ+PC90cj48L3RhYmxlPjwvdGQ+PHRkIHN0eWxlPSJib3JkZXItcmlnaHQ6IDEuMHB4IHNvbGlkICNjMGJlYmY7Ym9yZGVyLWJvdHRvbTogMS4wcHggc29saWQgI2MwYmViZjt3aWR0aDogMTg2LjBweDtwYWRkaW5nLWJvdHRvbTogNS4wcHg7Ij48dGFibGUgY2VsbHNwYWNpbmc9IjAiIGNlbGxwYWRkaW5nPSIwIiBzdHlsZT0id2lkdGg6IDEwMC4wJTtib3JkZXI6IDA7YmFja2dyb3VuZC1jb2xvcjogI2ZmZmZmZjsiPjx0cj48dGQ+PGRpdiBzdHlsZT0iaGVpZ2h0OiAyNS4wcHg7bGluZS1oZWlnaHQ6IDMwLjBweDtvdmVyZmxvdzogaGlkZGVuO3RleHQtYWxpZ246IGNlbnRlcjt3aGl0ZS1zcGFjZTogbm93cmFwOyI+PGEgc3R5bGU9ImRpc3BsYXk6IGlubGluZS1ibG9jaztjb2xvcjogI2ZmMDAwMDtmb250LXNpemU6IDE0LjBweDtmb250LXdlaWdodDogYm9sZDtwYWRkaW5nLXJpZ2h0OiAxMC4wcHg7dGV4dC1kZWNvcmF0aW9uOiBub25lOyIgdGFyZ2V0PSJfYmxhbmsiIGhyZWY9Imh0dHA6Ly9pdGVtLnRhb2Jhby5jb20vaXRlbS5odG0/aWQ9NTY2MDI3ODUwOTA4Ij7QryDQtNGD0LzQsNGOLCDRgtC10LHQtSDQv9C+0L3RgNCw0LLQuNGC0YHRjzwvYT48L2Rpdj48L3RkPjwvdHI+PHRyPjx0ZCBzdHlsZT0id2lkdGg6IDE4MC4wcHg7aGVpZ2h0OiAxODAuMHB4O3RleHQtYWxpZ246IGNlbnRlcjsiPjxhIHN0eWxlPSJ0ZXh0LWRlY29yYXRpb246IG5vbmU7dmVydGljYWwtYWxpZ246IG1pZGRsZTsiIHRhcmdldD0iX2JsYW5rIiBocmVmPSJodHRwOi8vaXRlbS50YW9iYW8uY29tL2l0ZW0uaHRtP2lkPTU2NjAyNzg1MDkwOCI+PGltZyBhbHQ9IiIgc3JjPSJodHRwczovL2ltZy5hbGljZG4uY29tL2Jhby91cGxvYWRlZC9pMy8xMzk2NjM5NDkvVEIxSldXT2ViU1lCdU5qU3NwaVhYWE56cFhhXyEhMC1pdGVtX3BpYy5qcGdfMTcweDE3MC5qcGciPjwvYT48L3RkPjwvdHI+PHRyPjx0ZD48cCBzdHlsZT0icGFkZGluZzogMDttYXJnaW46IDA7d2lkdGg6IDE3NS4wcHg7aGVpZ2h0OiAyMC4wcHg7bGluZS1oZWlnaHQ6IDIwLjBweDtvdmVyZmxvdzogaGlkZGVuO3RleHQtaW5kZW50OiA1LjBweDt3aGl0ZS1zcGFjZTogbm93cmFwOyI+PGEgc3R5bGU9ImNvbG9yOiAjNGU0ZTRlO2ZvbnQtd2VpZ2h0OiBib2xkO3RleHQtZGVjb3JhdGlvbjogbm9uZTsiIHRhcmdldD0iX2JsYW5rIiBocmVmPSJodHRwOi8vaXRlbS50YW9iYW8uY29tL2l0ZW0uaHRtP2lkPTU2NjAyNzg1MDkwOCI+0JTQvtC80L7RhdC+0LfRj9C50YHRgtCy0LXQvdC90YvQtSDQvNGL0YjQuCDQu9C+0LLQu9C4INC80YvRiNC4INC70L7QstC70Lgg0LzRi9GI0Lgg0YEg0LLRi9GB0L7QutC+0Lkg0Y3RhNGE0LXQutGC0LjQstC90L7RgdGC0YzRjiDQv9C+0LvQvdC+0YHRgtGM0Y4g0LDQstGC0L7QvNCw0YLQuNGH0LXRgdC60LDRjyDQu9C+0LLRhtCwINC20LXQu9C10LfQvdC+0Lkg0LzRi9GI0LgsINGH0YLQvtCx0Ysg0L/QvtC50LzQsNGC0Ywg0LjQvdGB0YLRgNGD0LzQtdC90YLRiyDQtNC70Y8g0LvQvtCy0LvQuCDQvNGL0YjQuCDQutC70LXRgtC60Lgg0LTQu9GPINC80YvRiNC4PC9hPjwvcD48ZGl2IHN0eWxlPSJoZWlnaHQ6IDI1LjBweDttYXJnaW4tdG9wOiA0LjBweDt3aGl0ZS1zcGFjZTogbm93cmFwO3BhZGRpbmc6IDAgNS4wcHg7IiBjbGFzcz0icHJpY2VzIj48cCBzdHlsZT0icGFkZGluZzogMDttYXJnaW46IDA7Y29sb3I6ICNmZTNlNGM7aGVpZ2h0OiAyMC4wcHg7bGluZS1oZWlnaHQ6IDIwLjBweDt0ZXh0LWluZGVudDogNS4wcHg7ZmxvYXQ6IGxlZnQ7Ij48c3BhbiBjbGFzcz0icHJpY2UiPjxzcGFuIGNsYXNzPSJpY29uIj7vv6U8L3NwYW4+PGkgc3R5bGU9ImZvbnQ6IDE4LjBweCBib2xkIHZlcmRhbmEgYXJpYWw7Ij4xNC44PC9pPjwvc3Bhbj48L3A+PHAgc3R5bGU9InBhZGRpbmc6IDA7bWFyZ2luOiAwO2NvbG9yOiAjOTk5OTk5O2ZvbnQ6IDEyLjBweCBib2xkO21hcmdpbi1sZWZ0OiA1LjBweDttYXJnaW4tdG9wOiAzLjBweDtmb250LXdlaWdodDogYm9sZDtmbG9hdDogbGVmdDsiPjxzcGFuIHN0eWxlPSJmb250LXdlaWdodDogbm9ybWFsO3RleHQtZGVjb3JhdGlvbjogbGluZS10aHJvdWdoOyIgY2xhc3M9InByaWNlIj48c3BhbiBjbGFzcz0iaWNvbiI+77+lPC9zcGFuPjxpPjI5LjY8L2k+PC9zcGFuPjwvcD48L2Rpdj48ZGl2IHN0eWxlPSJ0ZXh0LWFsaWduOiBjZW50ZXI7d2lkdGg6IDE4MC4wcHg7IiBjbGFzcz0iaXRlbS1nb3UiPjx0YWJsZSBjZWxsc3BhY2luZz0iMCIgY2VsbHBhZGRpbmc9IjAiIGJhY2tncm91bmQ9Imh0dHBzOi8vaW1nLmFsaWNkbi5jb20vaW1nZXh0cmEvaTEvMjA4NDEzOTgvVEIyaFNtSFhWWFhYWFhNWHBYWFhYWFhYWFhYLTIwODQxMzk4LnBuZyIgc3R5bGU9IndpZHRoOiAxMDAuMCU7YmFja2dyb3VuZC1yZXBlYXQ6IG5vLXJlcGVhdDtiYWNrZ3JvdW5kLXBvc2l0aW9uOiA1LjBweCAtMzAwLjBweDsiPjx0cj48dGQ+PC90ZD48L3RyPjwvdGFibGU+PC9kaXY+PC90ZD48L3RyPjwvdGFibGU+PC90ZD48dGQgc3R5bGU9ImJvcmRlci1yaWdodDogMS4wcHggc29saWQgI2MwYmViZjtib3JkZXItYm90dG9tOiAxLjBweCBzb2xpZCAjYzBiZWJmO3dpZHRoOiAxODYuMHB4O3BhZGRpbmctYm90dG9tOiA1LjBweDsiPjx0YWJsZSBjZWxsc3BhY2luZz0iMCIgY2VsbHBhZGRpbmc9IjAiIHN0eWxlPSJ3aWR0aDogMTAwLjAlO2JvcmRlcjogMDtiYWNrZ3JvdW5kLWNvbG9yOiAjZmZmZmZmOyI+PHRyPjx0ZD48ZGl2IHN0eWxlPSJoZWlnaHQ6IDI1LjBweDtsaW5lLWhlaWdodDogMzAuMHB4O292ZXJmbG93OiBoaWRkZW47dGV4dC1hbGlnbjogY2VudGVyO3doaXRlLXNwYWNlOiBub3dyYXA7Ij48YSBzdHlsZT0iZGlzcGxheTogaW5saW5lLWJsb2NrO2NvbG9yOiAjZmYwMDAwO2ZvbnQtc2l6ZTogMTQuMHB4O2ZvbnQtd2VpZ2h0OiBib2xkO3BhZGRpbmctcmlnaHQ6IDEwLjBweDt0ZXh0LWRlY29yYXRpb246IG5vbmU7IiB0YXJnZXQ9Il9ibGFuayIgaHJlZj0iaHR0cDovL2l0ZW0udGFvYmFvLmNvbS9pdGVtLmh0bT9pZD0xOTIzMTE5NTUzMSI+0K8g0LTRg9C80LDRjiwg0YLQtdCx0LUg0L/QvtC90YDQsNCy0LjRgtGB0Y88L2E+PC9kaXY+PC90ZD48L3RyPjx0cj48dGQgc3R5bGU9IndpZHRoOiAxODAuMHB4O2hlaWdodDogMTgwLjBweDt0ZXh0LWFsaWduOiBjZW50ZXI7Ij48YSBzdHlsZT0idGV4dC1kZWNvcmF0aW9uOiBub25lO3ZlcnRpY2FsLWFsaWduOiBtaWRkbGU7IiB0YXJnZXQ9Il9ibGFuayIgaHJlZj0iaHR0cDovL2l0ZW0udGFvYmFvLmNvbS9pdGVtLmh0bT9pZD0xOTIzMTE5NTUzMSI+PGltZyBhbHQ9IiIgc3JjPSJodHRwczovL2ltZy5hbGljZG4uY29tL2Jhby91cGxvYWRlZC9pMi9UMW1CYy5GQmRjWFhYWFhYWFhfISEwLWl0ZW1fcGljLmpwZ18xNzB4MTcwLmpwZyI+PC9hPjwvdGQ+PC90cj48dHI+PHRkPjxwIHN0eWxlPSJwYWRkaW5nOiAwO21hcmdpbjogMDt3aWR0aDogMTc1LjBweDtoZWlnaHQ6IDIwLjBweDtsaW5lLWhlaWdodDogMjAuMHB4O292ZXJmbG93OiBoaWRkZW47dGV4dC1pbmRlbnQ6IDUuMHB4O3doaXRlLXNwYWNlOiBub3dyYXA7Ij48YSBzdHlsZT0iY29sb3I6ICM0ZTRlNGU7Zm9udC13ZWlnaHQ6IGJvbGQ7dGV4dC1kZWNvcmF0aW9uOiBub25lOyIgdGFyZ2V0PSJfYmxhbmsiIGhyZWY9Imh0dHA6Ly9pdGVtLnRhb2Jhby5jb20vaXRlbS5odG0/aWQ9MTkyMzExOTU1MzEiPtCR0L7Qu9GM0YjQvtC5INC/0LjRidC10LLQvtC5INCz0LXRgNC80LXRgtC40Log0LfQsNC60YPRgdC60Lgg0LfQsNC60YPRgdC60Lg8L2E+PC9wPjxkaXYgc3R5bGU9ImhlaWdodDogMjUuMHB4O21hcmdpbi10b3A6IDQuMHB4O3doaXRlLXNwYWNlOiBub3dyYXA7cGFkZGluZzogMCA1LjBweDsiIGNsYXNzPSJwcmljZXMiPjxwIHN0eWxlPSJwYWRkaW5nOiAwO21hcmdpbjogMDtjb2xvcjogI2ZlM2U0YztoZWlnaHQ6IDIwLjBweDtsaW5lLWhlaWdodDogMjAuMHB4O3RleHQtaW5kZW50OiA1LjBweDtmbG9hdDogbGVmdDsiPjxzcGFuIGNsYXNzPSJwcmljZSI+PHNwYW4gY2xhc3M9Imljb24iPu+/pTwvc3Bhbj48aSBzdHlsZT0iZm9udDogMTguMHB4IGJvbGQgdmVyZGFuYSBhcmlhbDsiPjYuOTwvaT48L3NwYW4+PC9wPjxwIHN0eWxlPSJwYWRkaW5nOiAwO21hcmdpbjogMDtjb2xvcjogIzk5OTk5OTtmb250OiAxMi4wcHggYm9sZDttYXJnaW4tbGVmdDogNS4wcHg7bWFyZ2luLXRvcDogMy4wcHg7Zm9udC13ZWlnaHQ6IGJvbGQ7ZmxvYXQ6IGxlZnQ7Ij48c3BhbiBzdHlsZT0iZm9udC13ZWlnaHQ6IG5vcm1hbDt0ZXh0LWRlY29yYXRpb246IGxpbmUtdGhyb3VnaDsiIGNsYXNzPSJwcmljZSI+PHNwYW4gY2xhc3M9Imljb24iPu+/pTwvc3Bhbj48aT4xMy44PC9pPjwvc3Bhbj48L3A+PC9kaXY+PGRpdiBzdHlsZT0idGV4dC1hbGlnbjogY2VudGVyO3dpZHRoOiAxODAuMHB4OyIgY2xhc3M9Iml0ZW0tZ291Ij48dGFibGUgY2VsbHNwYWNpbmc9IjAiIGNlbGxwYWRkaW5nPSIwIiBiYWNrZ3JvdW5kPSJodHRwczovL2ltZy5hbGljZG4uY29tL2ltZ2V4dHJhL2kxLzIwODQxMzk4L1RCMmhTbUhYVlhYWFhYTVhwWFhYWFhYWFhYWC0yMDg0MTM5OC5wbmciIHN0eWxlPSJ3aWR0aDogMTAwLjAlO2JhY2tncm91bmQtcmVwZWF0OiBuby1yZXBlYXQ7YmFja2dyb3VuZC1wb3NpdGlvbjogNS4wcHggLTMwMC4wcHg7Ij48dHI+PHRkPjwvdGQ+PC90cj48L3RhYmxlPjwvZGl2PjwvdGQ+PC90cj48L3RhYmxlPjwvdGQ+PC90cj48L3RhYmxlPjwvdGQ+PC90cj48dHI+PHRkIHN0eWxlPSJ0ZXh0LWFsaWduOiByaWdodDsiPjwvdGQ+PC90cj48L3RhYmxlPjwvZGl2PjwvdGQ+PC90cj48L3RhYmxlPjwvcD4=
Продавец:惠美家居 源头工厂
Рейтинг:

Всего отзывов:0
Положительных:0
Добавить в корзину
- Информация о товаре
- Фотографии
![]()
![]() |
![]()
![]()
![]()
![]()
![]()
![]() | |||||||||||||||||||||
![]() | |||||||||||||||||||||
![]() |
| ||||||||||||||||||||
| | |||||||||||||||||||||
![]() | |||||||||||||||||||||
![]() ![]() ![]()
![]() ![]() ![]()
![]() ![]() ![]() ![]()
| |||||||||||||||||||||